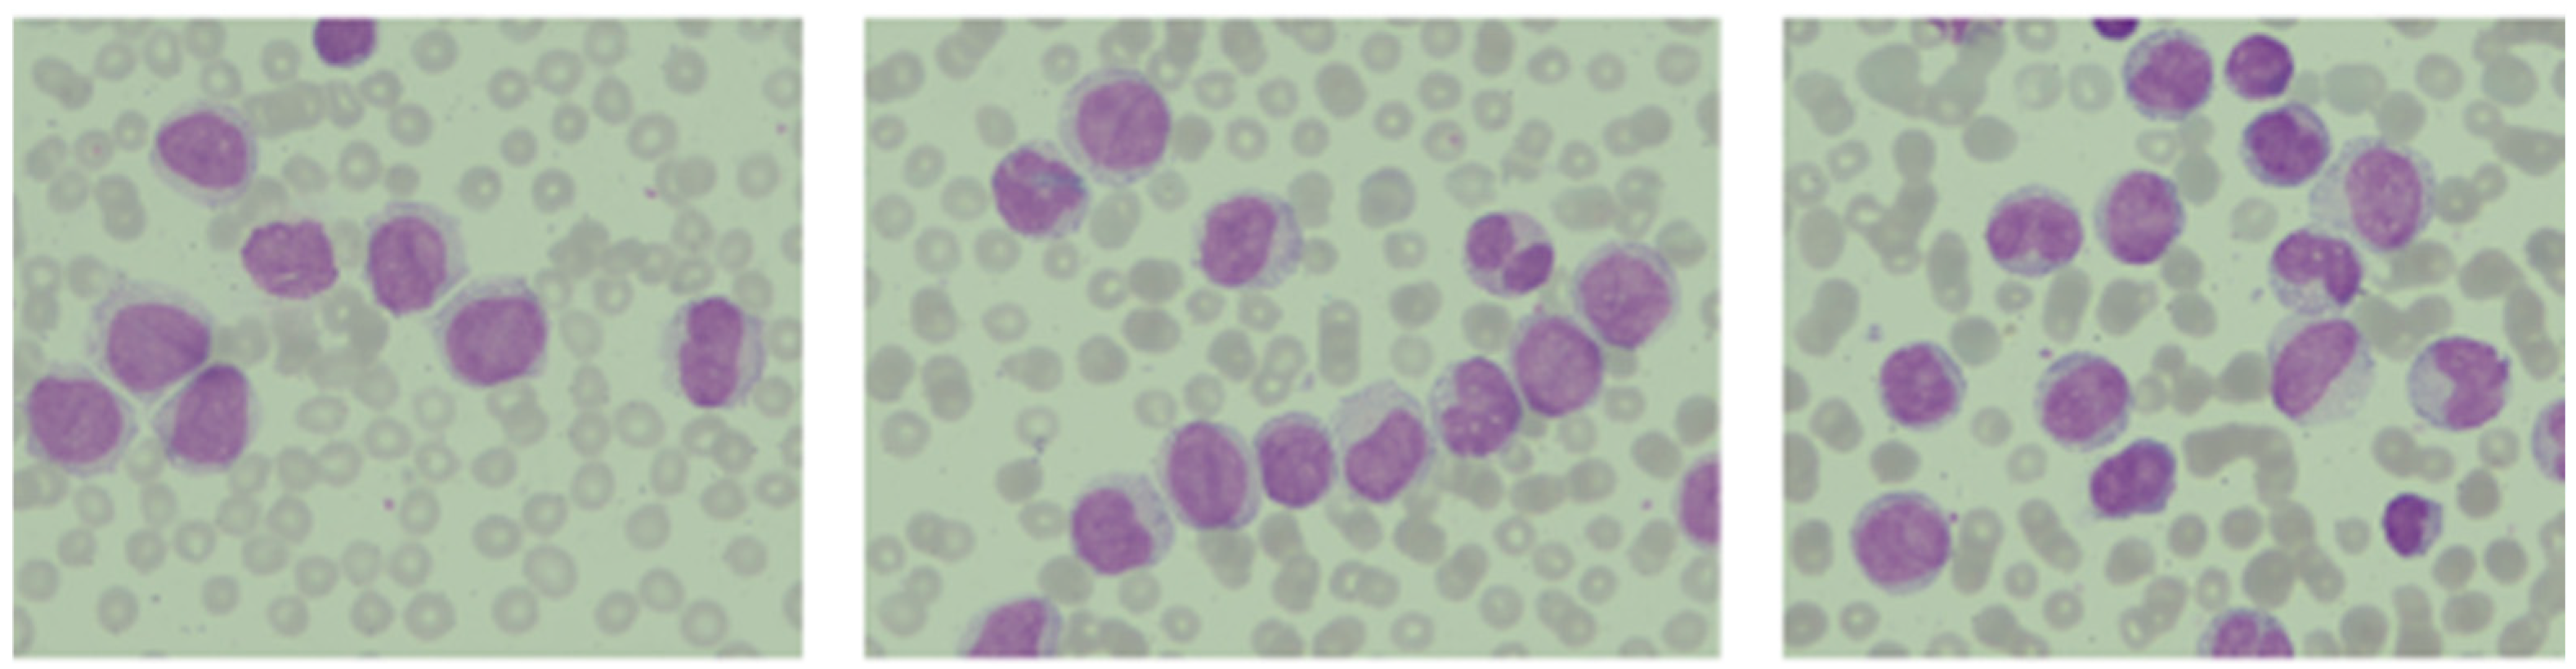
Ijms 26 09269 g005 Ijms 26 09269 g005

Abstract
Acute myeloid leukemia (AML), the second most common type of leukemia in children, is a heterogeneous disease known to be caused by genetic, epigenetic, and transcriptional changes, predominantly somatic and germline abnormalities. Despite significant improvement of overall survival rates, the prognosis of pediatric AML remains unfavorable in comparison with acute lymphoblastic leukemia (ALL), especially in relapsed or refractory settings. The current status and future directions are focused on establishing an accurate diagnosis and treatment strategies based on the genomic background. Next-generation sequencing (NGS) technologies enable a broader understanding of the basis of the disease for the purpose of determining pathology-associated mutations and additional prognostic biomarkers in pediatric AML. This review focuses on providing an overview of the known and possible prognostic factors, as well as genetic landscape of pediatric AML patients and how it can be used to accurately differentiate and risk stratify patients. It also presents potential candidate modifications for risk adjustment and targeted therapy. Furthermore, we describe in this article a case of a 22-month-old male patient with relapsed M5 high-risk group (HRG) AML with complex karyotype. Due to belonging to the HRG, as well as unsatisfactory chemotherapy response, the patient underwent matched unrelated donor (MUD) stem cell transplantation (SCT).
1. Introduction
Despite significant progress in identifying prognostic and predictive markers and the introduction of new therapies, mortality associated with AML remains relatively unchanged. AML continues to be one of the malignancies with the poorest prognosis, with a five-year overall survival (OS) rate of only about 33% [1,2,3]. Among pediatric patients, the overall survival rate has steadily been increasing and currently reaches approximately 75% in developed countries; by comparison, long-term survival rates were about 50% in the 1990s [4,5]. In children with ALL, this rate exceeds 90% [6].
AML is a heterogeneous, clonal malignancy originating from immature precursor cells of the myeloid lineage. It is characterized by uncontrolled proliferation and accumulation of blasts in the bone marrow, leading to impaired normal hematopoiesis [7,8]. Statistics from the National Institutes of Health (NIH) estimate that 22,010 new cases of AML will be diagnosed in 2025. AML is most commonly diagnosed among individuals aged 65–74, with this age group accounting for 26.6% of new cases. The incidence rate is 4.3 new cases per 100,000 men and women annually. Patients under the age of 20 represent only 4.1% of newly diagnosed cases [1,9]. The incidence of AML among infants, children aged 1 to 4 years, and in the 5–9-year-old age group is approximately 1.5, 0.9, and 0.4 cases per 100,000 individuals per year, respectively [10]. Among children, AML accounts for approximately 20% of all leukemia cases [11].
In children, there is no difference in the incidence of AML between sexes. While the development of AML can be associated with certain congenital chromosomal abnormalities (e.g., trisomy 21), inherited predisposition syndromes, germline mutations or structural gene alterations (such as those seen in inherited bone marrow failure syndromes), as well as acquired conditions or prior exposure to cytotoxic therapy, the vast majority of pediatric AML cases arise de novo, without a clearly identifiable cause. The pathogenesis is primarily driven by a stepwise accumulation of genetic and chromosomal alterations in immature myeloid precursor cells, ultimately leading to malignant transformation [12,13].
Despite effective initial treatment, approximately 24–50% of young patients experience a relapse, and the chances of long-term survival in this group are estimated to be only around 30% [5,14,15]. Clonal evolution plays a significant role in the relapse process, referring to dynamic changes in the genetic composition of the leukemic cell population in response to therapeutic pressure [16]. In patients who experience relapse, an emergence of new, previously undetectable subclones with mutations in genes such as FLT3-ITD, NRAS, ASXL3, or KIT is frequently observed [17,18]. Another factor contributing to AML relapse is the bone marrow microenvironment, which can protect leukemic cells from the effects of anticancer drugs. Studies indicate that the stromal and immunological components of this environment create a specific protective niche for leukemic blasts, significantly limiting the effectiveness of therapy [19]. In some patients, relapse may be caused by insufficient treatment intensity or the absence of hematopoietic stem cell transplantation (HSCT) in situations where it would have been indicated [20].
In current therapeutic protocols, pediatric patients with AML are divided into three main prognostic groups: favorable, intermediate, and adverse. Each of these categories is characterized by specific molecular and cytogenetic abnormalities that influence the course of the disease and the response to treatment [21].
2. Prognostic Factors
The overall prognosis of pediatric AML has improved significantly in recent years. One reason for this is an effective approach to risk stratification. In order to accurately assign patients to a specific risk group, it is necessary to start by identifying the various prognostic factors that will be associated, among other things, with the patient’s resistance to specific types of treatment. Such factors can be further divided into patient-related factors and disease-related factors.
2.1. Patient-Related Factors
In previous years, many studies reported the presence of a correlation between age and clinical characteristics of pediatric AML. Patients over the age of 10 had significantly worser outcomes and more treatment-related toxicities than their younger counterparts [22,23,24]. However, a study by Wang et al. supports the theory that infants, as well as young children, have a poorer overall prognosis. [25]. Infants and children aged 1 to 2 years oftentimes present adverse disease characteristics, such as higher white blood cell (WBC) counts, hepatosplenomegaly, or central nervous system (CNS) infiltration [26,27]. Furthermore, unfavorable outcomes of infant patients frequently stem from high-risk cytogenetic features associated with chemoresistance and heightened relapse rates. A retrospective study by Pawińska-Wąsikowska et al. analyzed AML patients aged 0 to 18 years treated in pediatric oncology centers in Poland from 2015 to 2022. The patients were risk-stratified based on cytogenetics of leukemic blasts and, among all four patient age groups, the infant group had the highest percentage of patients belonging to the HRG, 52% (n = 16) vs. 38.5% (n = 35) in the younger children group vs. 40.5% (n = 24) in the older children group vs. 33% (n = 13) in the adolescent group. Patients in the infant group obtained the lowest complete remission (CR) rate of 87%, compared to 95% in the younger children, however, the younger children group showed the highest relapse rate of 20.9%, compared to infants, older children, and adolescents (19.4% vs. 1.6% vs. 17.9%, respectively). More than half of the infant patients (51.6%) presented with the M5 AML subtype [28], which supports previous findings, indicating that infant AML is related to high frequencies of M4, M5, and M7 subtypes in the French–American–British (FAB) classification [26,27]. Unfortunately, the prognosis of such patients remains below expectations, with the OS rate at about 31% [29]. In a study by Liu et al. regarding patients with AML-M5, poorer OS and progression-free survival (PFS) were observed in high-risk patients with any of the following: MLL-R, FLT3-ITD, hyperleukocytosis, bone marrow (BM) blast percentage ≥ 70%, or age ≤ 3 years [30].
In light of recent reports, there is also a link between the race of patients and the course of their disease. Cytogenetic lesions in children with AML tend to differ by race-ethnicity. Regarding high-risk genetic features, Black patients were twice as likely to have −5/5q- or −7/7q- AML and five times more likely to have KMT2A rearrangement t(6;11)(q27;q23) AML in comparison with non-Black patients [31]. Moreover, as regards favorable genetic features, such as t(8;21) AML [31], NPM1-mutated FLT3-ITDlo/no AML [32], and RUNX1::RUNX1T1 fusion AML [33], the 3-year OS among Black patients still remained lower than that of non-Black ones. In addition to survival rates, time points of illness during which events contributing to poor survival occurred varied by race-ethnicity. Studies show that Black patients have the highest mortality from AML at diagnosis and in the first month after diagnosis, in contrast to non-Black patients, who have higher mortality rates later in the course of the disease [31,34,35]. A study by Lamba et al. suggests that racial disparities stem from dissimilarities in pharmacogenomics, as 51 of 70 examined Black patients presented with low scores of ACS10, cytarabine pharmacogenomics-based polygenic score, compared to 82 of 273 examined White patients. It was found that low ACS10 score correlated with considerably worse 5-year event-free survival (EFS) rates in comparison with those with high scores (42.4% vs. 70.0%) [36].
At present, it is emphasized in an accumulating number of studies that nutritional status of pediatric patients at the initial diagnosis of ALL impacts leukemia relapse and disease-related death [37,38]. Furthermore, previous studies in AML also showed that a body mass index (BMI) indicating either underweight or overweight at diagnosis correlated with poorer overall survival and higher treatment-related mortality, particularly due to infections and hemorrhage [39]. Although the negative impact of both underweight and overweight on the course of the disease has been confirmed, more recent studies do not clearly determine the impact of weight on specific long-term patient outcomes. One study found that, although a higher body weight was associated with lower disease resistance/relapse, it was also associated with a higher mortality rate during remission. Moreover, greater weight loss was significantly associated with death during the first remission [40]. In a study by Wen et al. children with low BMIs at the initial diagnosis and induction chemotherapy stages and with overweight at the initial diagnosis showed relatively lower 3-year EFS, 3-year relapse-free survival (RFS), and 3-year OS rates [41]. Despite a smaller AML patient cohort, the systematic review and meta-analysis summarizing results from 17 studies on the impact of body weight on pediatric patients with leukemia by Dong et al. revealed that underweight or obese patients showed a greater mortality risk and lower rates of EFS compared to children with normal BMIs. No difference in mortality risk was noted in overweight children. The risk of relapse was similar regardless of the BMI [42]. Fortunately, even though unhealthy BMI may well reduce the prognosis of pediatric AML patients, the recent progress in leukemia treatment and supportive care has significantly reduced the prognostic impact of the BMI at the time of the initial diagnosis [40,41].
AML typically presents in a sporadic context. However, in recent years there has been a growing understanding that certain inherited or de novo germline mutations significantly increase the incidence of myeloid neoplasms, such as AML [13,43]. In terms of genetic mutations, the development of AML has most often been associated with trisomy 21, as AML is 6–83 times more common among patients with Down syndrome than in the general population [44,45,46]. Moreover, there are some other genetic syndromes that have been linked with myeloid malignancy predisposition, such as Fanconi anemia [47,48], Bloom syndrome [49], Shwachman–Diamond syndrome [50], or Noonan syndrome [51], among others. A summary of selected, recently described germline mutations associated with the development of pediatric AML is presented in Table 1.

Table 1.
Summary of selected recently described germline mutations associated with the development of pediatric AML.
2.2. Disease-Related Factors
Hyperleukocytosis, typically defined as a WBC count greater than 100,000 cells/µL [88], occurring in 12.6 to 27.4% of pediatric AML patients [89,90], is a documented unfavorable prognostic factor [90,91], but its impact on the prognosis of the disease remains uncertain. Because of interaction between leukemic blasts and endothelial cells, such elevated WBC counts oftentimes lead to leukostasis, i.e., cells accumulating in the capillaries and blocking blood flow, disseminated intravascular coagulation (DIC), secondary hemorrhages, respiratory and neurological complications, and/or tumor-lysis syndrome (TLS), in comparison to patients with lower WBC counts [89,92]. In a study by Zhang et al. analyzing pediatric AML patients with different criteria of hyperleukocytosis, patients with WBC counts of 50,000–100,000 cells/µL and WBC counts ≥100,000 cells/µL had similar CR rates (71.4% vs. 75.4%) and 5-year EFS rates (78.0% ± 5.3% vs. 81.1% ± 2.9%). Patients with hyperleukocytosis presented a higher rate of relapsed/refractory disease and mortality than those without hyperleukocytosis [90]. Another study found an association between hyperleukocytosis and significantly inferior 5-year EFS and a trend of inferior OS of patients compared to those without hyperleukocytosis [93]. Moreover, significant leukocytosis was found to be associated with an age below 1 year and corresponded to a higher proportion of FAB subtypes of M1, M4, M5, intermediate chromosomes, FLT3-ITD/TKD, CEBPA mutation, inv (16), MLL, and gene fusion of CBFB-MYH11 and NUP98-NSD1 [90,93,94]. It is important to note that lower EFS rates caused by greatly elevated WBC counts were found irrelevant of cytogenetics status [93] but were connected with the age of patients at the time of diagnosis, with children aged 1 to 9 years having higher 5-year EFS rates [91]. Additionally, a WBC count of ≥100,000 cells/µL at the time of diagnosis was a risk factor of disease relapse [95].
2.3. Genetics of Pediatric AML
Despite remarkable AML diversity, encompassing everything from clinical manifestations to morphology, some chromosomal and molecular alterations are recurrent and characteristic of pediatric AML. Such alterations include t(15;17)(q24.1;q21.2) with a PML-RARA fusion gene [96], AML with core-binding factor (CBF) with RUNX1-RUNX1T1 and CBFB-MYH11 fusion genes [97], 11.q23 rearrangements (KMT2A) [98], inv(16) (p13.3q24.3) with fusion gene CBFA2T3-GLIS2 [99], 11p.15 rearrangements (NUP98) [100], aneuploidy in the form of monosomy 5/5q-, monosomy 7, or abnormal 12p [101].
On the other hand, the heterogeneity of AML is justified by the concept of clonal evolution of leukemic blasts [27,98,102], in which, during the course of the disease, subclones derived from a common ancestral clone are selected and expanded, acquiring distinct mutations that confer a survival advantage, leading to genetic differentiation within the cell lineage. Alongside disease progression, individual AML blast populations may undergo distinct patterns of clonal evolution, linear and branching, as well as an abundance of mutations at various time points [103,104]. Several studies [105] have analyzed whole-exome sequencing (WES) samples of blasts from pediatric AML patients at diagnosis, as well as later in the disease course, during remission and relapse. It has been shown that most dominant variants that arise during leukemia development persist from diagnosis until relapse, but subclonal modifications can also occur and develop later. This suggests that the genomic landscape at the time of relapse differs from the initial clone and can be influenced by the treatment [105,106]. Even though it is difficult to find recurrent single mutations, there are recurrent mutations in specific gene families [105]. Different concepts of clonal evolution of blasts and typical mutations [105,106,107,108] are presented in Figure 1.

Figure 1.
Models of clonal evolution in AML and mutations in specific gene families typical during clonal evolution. (a) Linear evolution describes the sequential acquisition of mutations. The relapse-originating cell is part of the major clone at diagnosis. (b) Branching evolution describes the eradication of the major clone and subsequent outgrowth of a secondary clone. The relapse-originating cell is part of a subclone at diagnosis. Created in https://BioRender.com, accessed 16 July 2025.
2.4. Measurable Residual Disease
The term measurable residual disease (MRD) refers to the presence of low, otherwise undetectable, levels of blast cells, from below 1:104 to 1:106 WBCs, and is an independent prognostic factor assessed after the diagnosis of AML, crucial for patient evaluation, risk stratification, and treatment planning [109]. After MRD evaluation, patients are typically divided into two groups: MRD < 0.1% and MRD ≥ 0.1%, though some studies used three categories when describing their MRD risk groups: MRD < 0.1%, MRD 0.1–1%, and MRD ≥ 1% [110,111]. An attainment of MRD negativity indicates the patient’s early treatment response [109] and correlates with greater long-term survival [110,112]. In a systematic review and meta-analysis of 81 publications regarding AML patients, the estimated 5-year disease-free survival (DFS) and OS rates in the MRD-negative patient group were significantly higher than in that with positive MRD, i.e., 64% vs. 25% and 68% vs. 34%, respectively [112]. Similarly, a systematic review of 13 publications solely regarding pediatric AML patients supports the statement that MRD-negative patients consequently obtain better clinical outcomes [110] It should be noted that the absence of MRD at assessment does not exclude a risk of disease relapse, as the relapse rate in the pediatric population who obtain MRD negativity after the induction cycle ranges between 20% and 25% [113]. MRD can be assessed using various tools, including the most commonly used multiparameter flow cytometry (MPFC). New methods and protocols are emerging, allowing MPFC to be supplemented with molecular techniques such as sensitive quantitative or digital droplet polymerase chain reaction (qPCR, ddPCR) methods and, more recently, error-correcting NGS technologies to identify gene mutations associated with AML. Unfortunately, these methods have not yet been standardized qualitatively or quantitatively, which hinders their application in clinical practice [114]. Major MRD-assessment technologies are showcased in Table 2.

Table 2.
Summary of selected studies on technologies used to assess MRD in AML.
3. Risk Stratification in Pediatric AML
Risk stratification is one of the key components of effective AML treatment. Current risk stratification systems in pediatric AML are based on a combination of leukemia-specific cytogenetic and molecular abnormalities, along with treatment response assessed through MRD evaluation. In 2017, an updated version of the European Leukemia Net classification (ELN 2017) was published, introducing a standardized risk categorization for AML, dividing patients into three main prognostic groups: favorable, intermediate, and adverse [21]. Each group is defined by a distinct genetic profile that plays a crucial role in disease progression, anticipated treatment response, and the selection of therapy intensity [21].
One of the best-characterized chromosomal abnormalities in AML is the t(8;21)(q22;q22) translocation, typically associated with the M2 morphological subtype. This translocation results in the formation of the RUNX1::RUNX1T1 fusion gene, which was among the first to be utilized in clinical practice for the detection of MRD [122]. The t(8;21) translocation occurs in approximately 10–12% of pediatric patients with AML [97]. This aberration is typically associated with a reduced white blood cell count and the presence of large blast cells characterized by basophilic cytoplasm, numerous azurophilic granules, and Auer rods [123,124]. Treatment of AML patients with the t(8;21) mutation typically involves induction regimens based on anthracyclines and cytarabine, followed by two to four cycles of consolidation therapy using high-dose cytarabine. In selected cases, treatment may be supplemented with gemtuzumab ozogamicin (GO) [125].
The chromosomal abnormality inv(16)(p13;q22) or t(16;16)(p13.1;q22) leads to the formation of the CBFβ-MYH11 fusion gene [126]. The MYH11 gene encodes the smooth muscle myosin heavy chain (SMMHC), whereas the CBFβ gene encodes the β subunit of the CBF [127]. In patients with the inv(16)(p13;q22) translocation, markedly elevated white blood cell and monocyte counts are often observed, along with the presence of eosinophils displaying abnormal morphology. Eosinophils at various stages of maturation can be seen. These features are characteristic of the leukemia subtype known as AML M4Eo [128].
AML with t(8;21)(q22;q22) and AML with inv(16)(p13.1q22)/t(16;16)(p13.1;q22) are collectively referred to as CBF-AML [129]. CBF-AML accounts for approximately 15% of AML cases in adults and 25–30% in children [130]. The CBF AML subtype is associated with a better prognosis, but it exhibits similar relapse rates of approximately 30%, comparable to other AML subtypes [95,131].
Other abnormalities classified as favorable prognostic factors include mutations in the CEBPA gene and the NPM1 gene. Both of these mutations are considered cytogenetically normal aberrations in AML. CEBPA is a transcription factor that plays a key role in cytodifferentiation, that is, maturation of myeloid cell precursors during hematopoiesis. It regulates the expression of genes specific to granulocytes, enabling their proper differentiation [132]. CEBPA mutations occur in 5–10% of pediatric patients, with double mutants showing an 80% 5-year OS rate [133,134]. Nucleophosmin 1 (NPM1) is a protein responsible for transport between the nucleus and the cytoplasm. It is primarily localized in the nucleolus, where it performs a variety of essential functions [135]. Mutations in the NPM1 gene occur in various variants, but all involve an insertion in its C-terminal region. This alteration causes abnormal translocation of the protein from the nucleus to the cytoplasm, a phenomenon referred to as the NPMc+ phenotype [136].
FLT3 is a receptor tyrosine kinase activated by a transmembrane ligand, physiologically expressed primarily on hematopoietic stem and progenitor cells. It plays a critical role in regulating the early stages of myeloid and lymphoid lineage development. Mutations in FLT3 lead to constitutive activation of its tyrosine kinase activity, resulting in uncontrolled cellular proliferation. The two major types of FLT3 mutations are internal tandem duplications (FLT3-ITD) within the juxtamembrane domain and point mutations or deletions in the tyrosine kinase domain (FLT3-TKD) [137]. FLT3-ITD mutations are common in pediatric AML, accounting for approximately 10–20% of pediatric AML cases. The 5-year OS is only 30–40% [134].
The KMT2A gene (formerly MLL), located on chromosome 11q23, encodes a protein involved in the regulation of developmental gene expression, including key genes of the HOX family, which are critical for hematopoietic cell differentiation [138,139]. Translocations involving the 11q23 region are associated with an aggressive disease course, marked leukocytosis, and an increased risk of relapse, making this molecular variant a significant prognostic factor [138]. One such rearrangement is the t(11;19)(q23;p13.3) translocation, resulting in the KMT2A::MLLT1 fusion, which is found in 1% of infants and 6% of children and adolescents with KMT2A-rearranged AML [140]. Fusion with the MLLT1 (ENL) gene results in the persistent recruitment of active transcriptional complexes through the YEATS domain, which recognizes acetylated lysine residues on histones. This leads to constitutive activation of gene expression programs that promote oncogenic transformation [141]. Currently, KMT2A fusions, including those involving MLLT1, are the focus of intensive research into targeted therapies. Of particular interest are menin inhibitors, which disrupt the interaction between MLL1 and the menin protein, leading to the suppression of aberrant HOX gene expression, as well as DOT1L inhibitors, which target the H3K79 methyltransferase enzyme recruited by KMT2A fusion complexes [139,142,143].
A summary of the ELN 2017 classification for risk stratification, including factors not listed above, is presented in Table 3.

Table 3.
Risk stratification based on molecular and cytogenetic abnormalities occurring in pediatric AML.
4. Risk-Adapted Treatment Approach
4.1. Upfront Therapy
Although upfront therapy in pediatric AML is a widely discussed topic among researchers, its backbone remains the same. The common standard comprises a chemotherapy regimen based on a combination of anthracycline with cytarabine [148]. Chemotherapy is quintessentially divided into two main stages, initiation, which aims at achieving initial remission, followed by consolidation, alternatively named intensification, which consists of additional courses of chemotherapy to eradicate residual disease. During the consolidation phase, high-risk patients receive allogenic HSCT (allo-HSCT) if a desirable donor is found and the patient achieved MRD negative remission [2,134]. Predominantly, the induction phase is based on the “7 + 3” regimen, which consists of a low-to-intermediate dose of cytarabine for seven days, followed by anthracycline for three days. This combination can be supplemented by a third medication, mostly etoposide [12]. However, the exact role of etoposide in the regimen is not yet fully understood and, what is more, in some studies it was decided not to include etoposide in the induction regimen [149]. The consolidation stage requires a nearly identical set of agents, i.e., mostly high-dose cytarabine with an optional addition of anthracyclines or other drugs. The exact number of chemotherapy courses, as well as inclusion of specific supplementary agents, is yet to be determined [12]. Anthracyclines used in this context include daunorubicin, idarubicin, and mitoxantron [150]. A newer approach considering anthracyclines promotes using liposomal daunorubicin, which was developed with an aim to allow dosage increase without intensifying adverse effects, mainly cardiotoxicity [151]. Studies have found that, compared to daunorubicin, including idarubicin and mitoxantrone in chemotherapy regimens did not provide improved treatment results, yet liposomal daunorubicin was associated with lower treatment-related mortality (TRM) in comparison to idarubicin [149]. Apart from anthracyclines, cytarabine is also available in a liposomal formulation. A combination of both agents, called CPX-351 together, with a daunorubicin to cytarabine molar ratio of 1:5, ensures elongated exposure time. The effectiveness and safety of such a solution was proven in adult patients with AML and current studies focusing on children also seem to be obtaining promising results after including CPX-351 in upfront therapy [152,153]. Another emerging approach to upfront therapy involves incorporation of GO, toxin-conjugated humanized IgG4 anti-CD33 monoclonal antibody, into conventional chemotherapy [154]. CD33 expression is highly associated with AML as it appears in up to 80% of patients but also indicates unfavorable prognosis. However, based on conducted research, GO improves EFS of pediatric patients with freshly diagnosed AML when added to induction and second courses of the consolidation phase of chemotherapy. This has led to approval by the Food and Drug Administration (FDA) for GO to be used in upfront treatment of AML in patients over 1 month old and for relapsed or refractory AML in patients over 2 years old [12,155,156]. Children’s Oncology Group (COG) suggests implementing GO in all AML patients, regardless of CD33 expression level [157]. Another promising approach targeting better treatment results in children with high allelic ratio (HAR) suffering from FLT3/ITD+ AML is an addition of sorafenib, multikinase type II inhibitor, to conventional chemotherapy. Such a combination provided a significant advancement in both EFS and DFS rates, with additional decline in relapse risk. Incorporations of GO or kinase inhibitors, such as sorafenib, into standard regimens are recommended to become a standard of care, however further research is still needed [158,159].
Nevertheless, not all novel strategies yield favorable outcomes. In trials in implementing bortezonib in conventional chemotherapy, not only did it not improve remission reduction rate but it also boosted treatment-related toxicities [160]. Another disappointing trial regarded inclusion of clofarabine, a second-generation purine nucleoside analogue, in the induction regimen (CLOF-based regimen) as it did not provide any encouraging conclusions [134,161].
Several studies showed a great advantage from intensification of conventional chemotherapy, especially since children tolerate high-intensity regimens better than adults. However, TRM was reported to be between 6% and 10% and short-term and long-term toxicity was found in around 40% of pediatric patients, which indicates that the intensity of conventional chemotherapy has reached its ceiling and the development of new approaches is mandatory [148,157]. It is also alarming that up to 40% of pediatric patients with de novo AML face relapse, despite intensified chemotherapy and expanded use of upfront allo-HSCT. The treatment of such relapses still poses a burdensome challenge [18]. Taking these facts into account, alternative treatment methods are being developed, with strong emphasis on personalized molecular targeted therapy, as well as immunotherapy [162].
4.2. Hematopoietic Stem Cell Transplant
Although there is ongoing research focused on finding newer treatment possibilities, allo-HSCT remains a necessary option for a certain group of patients [163]. The exact indications are not strictly set but most studies suggest that children with high-risk AML or relapsed AML are the most suitable recipients of allo-HSCT. Yet, a consensus is still missing for intermediate-risk AML in the context of allo-HSCT usage [157]. Since roughly 25% of pediatric AML is associated with disease relapse or is classified as high risk, allo-HSCT is an option for a prominent group of patients [164]. Allo-HSCT is generally performed in the first complete remission (CR1) as treatment augmentation when patients present unfavorable prognostic factors, including certain cytogenetic lesions, or their response to the induction phase of therapy is not satisfactory [165]. Research indicates that, with an increasing number of children undergoing HSCT, survival rates for AML are improving. This phenomenon is possible due to improving supportive care and better accessibility of donors [166]. The general objective of HSCT is to lessen relapse prevalence, improve graft-versus-leukemia (GVL) results and decrease graft-versus-host disease (GVHD), as relapse after HSCT is still a great issue leading to treatment failure, with more research regarding pre- and post-HSCT interventions being needed [167]. The cytotoxic effect of conditioning regimens and GVL’s effect from cytotoxic immune cells derived from the donor constitute the base for therapeutic outcomes of HSCT. If the transplant is performed during the first or second CR, DFS is expected to be at 60–70%, whereas TRM would be at 10–15% [168]. Presently, the standard for conditioning before HSCT includes either total body irradiation (TBI) or chemotherapeutics consisting of mixed alkylating agents. The most significant challenge is to find an accurate balance between toxic and therapeutic effects, as not conditioning forcefully enough can lead to disease relapse or graft rejection, whereas too aggressive conditioning can be the reason for tissue disruption or both acute and late life-threatening complications [169]. Standard conditioning with chemotherapeutics comprises regimens such as busulfan–cyclophosphamide (BuCy), busulfan–cyclophosphamide–melphalan (BuCyMel) and clofarabine–fludarabine–busulfan (CloFluBu). Results from studies comparing those regimens suggest that BuCy is associated with lower leukemia-free survival (LFS) as the relapse rate was higher, with younger age serving as a predictor of relapse, whereas ByCyMel and CloFluBu provided corresponding LFS rates. Moreover, CloFluBu yielded a decreased rate of acute GVHD, which correlated with busulfan therapeutic drug monitoring (TDM). As a result, CloFluBu is considered a promising, TBI-free regimen that is characterized by acceptable toxicity and a strong antileukemic effect [169,170]. In most cases the choice between myeloablative conditioning (MAC) and reduced-intensity conditioning (RIC) depends on the child’s general condition, comorbidities, relapse risk, and the ability to tolerate toxicity. If the patient does not show a genetic predisposition for increased toxicity, MAC is usually chosen for the first HSCT and RIC is chosen for the second HSCT or for patients with coexisting conditions [167]. With MAC, TRM is at a high rate, especially late TRM, while RIC is generally related to lower TRM, however, because of poorer disease management, the relapse risk is much more significant. Research suggests that, taking overall survival into consideration, results for MAC were considerably more favorable. After a long-term follow-up the children treated with the MAC regimen exhibited better survival rates than those receiving RIC, including children who were suitable for both MAC and RIC [171]. Despite advancement in conditioning regimens, relapse risk is still unsatisfactorily high and new approaches are being proposed. One approach indicates using prophylactic/pre-emptive low-dose azacitidine and donor lymphocyte infusion (DLI) as part of a maintenance regimen after HSCT to boost the GVL effect and consequently reduce relapse occurrence. The study proved that the method was not only safe but patients receiving maintenance also had improved overall survival as well as PFS compared to patients without this regimen [172]. Another novel strategy concerns an addition of targeted therapeutics, such as venetoclax and daratumumab, to the conditioning regimen, basing on the expression level of B-cell leukemia/lymphoma-2 (BCL-2) and CD38, as these targets frequently occur in pediatric AML. Although this preparative regimen was proved safe, there was no proof of long-term enhancement of post-transplant results [173].
4.3. Molecular Targeted Therapy
Research into targeted therapy aims at finding more personalized and accurate treatment strategies that work alongside conventional chemotherapy, intensifying its effects [151]. FLT3 mutations are among the most common genetic lesions in pediatric AML and are found in nearly 20–25% of patients [150]. The FLT3 gene encodes a transmembrane ligand-activated receptor tyrosine kinase, which is expressed by hematopoietic stem and progenitor cells in regular conditions, as it regulates hematopoiesis through several signaling pathways, such as PI3K, RAS, and STAT5. The two types of these mutations are an internal tandem duplication (FLT3-ITD) within the juxtamembrane (JM) domain and a mutation of the tyrosine kinase domain (FLT3-TKD). An interaction between FLT3 ligand and FLT3 receptor causes pathway activation leading to transcriptional changes which in the case of FLT3-ITD and FLT3-TKD mutations cause constant activation of FLT3 kinase and proliferation and survival of AML cells [174,175].
BCL-2 refers to a family of proteins involved in innate, mitochondrial apoptotic pathway regulation, whereas Myeloid cell leukemia 1 (MCL-1) is a member of that family. Both are antiapoptotic (prosurvival) proteins frequently present in hematologic malignancies, as their overexpression causes disruption of apoptosis by BCL-2 seizing proapoptotic BCL-2 homology 3 (BH3)-only proteins (BIM, BAD, BID), which suppresses oligomerization of pore-forming proteins (BAX and BAK) and mitochondrial outer membrane permeabilization (MOMP), thus promoting tumorigenesis and impaired reaction to chemotherapy. BCL-2 inhibitors aim at preventing this process [176,177].
Menin inhibitors are another possible targeted treatment strategy, designed primarily for patients with KMT2A rearrangements (KMT2Ar) or NPM1 mutations. Menin is a protein found in the cell nucleus, encoded by the MEN1 gene that facilitates the assembly and stabilization of various transcriptional and chromatin-modifying complexes. Notably, it interacts with the KMT2A (MLL) fusion protein complex, a critical epigenetic regulator involved in transcriptional control, particularly in leukemogenesis, using transcription factors HOXA9 and MEIS1. Inhibition of this interaction inhibits AML cell proliferation, thus reducing leukemia progress [151,178]. Mechanisms of action of FLT3 inhibitors, BCL2 inhibitors, and menin-KMT2A inhibitors and novel drugs [151,177,178,179,180,181] are shown in Figure 2.

Figure 2.
Mechanisms of action of FLT3 inhibitors, BCL2 inhibitors, and menin-KMT2A inhibitors. Created at https://BioRender.com, accessed 16 July 2025.
Since mutations of epigenetic regulators, as well as epigenetic alterations, are part of pediatric AML pathogenesis, epigenetic therapeutics are being developed, including hypomethylating agents (HMAs) and histone deacetylase (HDAC) inhibitors (HDACis). HMAs azacitidine (AZA) and decitabine (DEC) exert their antileukemic effects by reinstituting epigenetically silenced tumor suppressor genes, reversing gained DNA methylation patterns characteristic of malignant cells, and modulating the activity of mutated epigenetic enzymes. HDACis present a distinct mechanism of action, focusing on histone (de)acetylation modulation. Histone acetylation is part of several processes, including replication, DNA repair, apoptosis, or chromatin packing and cell differentiation. It is stabilized by histone deacetylases (HDACs) and histone acetyltransferases (HATs), adjusting gene expression. By suppressing HDACs, HDACis contribute to maintaining open chromatin conformation [182,183]. Mechanisms of action of epigenetic modifiers and novel drugs [150] are shown in Figure 3.

Figure 3.
Mechanisms of action of epigenetic modifiers. Created at https://BioRender.com, accessed 16 July 2025.
4.4. Immunotherapy
AML shows susceptibility to immune-based therapies, due to its distinct immunological profile, making it a promising target for immunotherapy. AML cells express both major histocompatibility complex (MHC) class I and II molecules, which is related to being recognized by T cells and vulnerable to T-cell-mediated cytotoxicity. The inherent immunological cooperation between myeloid cells and the immune system further supports the development of immunotherapeutic strategies aimed at targeting leukemic blasts. The effectiveness of conventional AML treatments, such as allo-HSCT and DLI, strengthens the role of immune effector cells, particularly T cells and natural killer (NK) cells, in detecting and eliminating leukemic cells, therefore highlighting AML’s sensitivity to immunotherapy [184].
There are currently several immune-based strategies being developed, including monoclonal and bispecific antibodies, chimeric antigen receptor T-cell (CAR-T) therapy, antibody–drug conjugates (ADCs), and application of checkpoint inhibitors. For antigen-specific monoclonal antibody therapy, CD33 and CD123 are the most common targets, as they are frequently expressed in AML and, therefore, have a significant potential to bring satisfactory treatment results. Research also includes using CD47 as a target, as leukemia cells tend to avoid phagocytosis, due to overexpression of “don’t eat me signals”, such as CD47. A further evolution of antibody-based regimens focuses on monoclonal antibodies developed with an aim to enhance antitumor activity by T-cell engagement. Such antibodies are called bispecific because as they present dual affinities for tumor cell antigens and immune effector cell antigens and comprise the minimal binding domains of two different antibodies on one, such as bispecific T-cell-engager (BiTE) antibodies, or two, such as dual-affinity retargeting (DART) antibody polypeptide chains. An application of ADCs is another method based on monoclonal antibodies, as they are connected to a cytotoxic payload with a cleavable linker. Such arrangement lets particularly cytotoxic drugs enter leukemia cells directly, resulting in cell death without unnecessary off-tumor toxicity. A newer approach involves using checkpoint inhibitors in patients with pediatric AML, because of their ability to boost immune reaction to tumor cells. Although this method has been proven successful in adult solid malignancies, it still needs to be further examined in AML. At present, nivolumab and pembrolizumab, anti-PD-1 antibodies, as well as ipilimumab, targeting CTLA-4, are being tested in clinical trials. CAR-T therapy is currently being studied as a potential immunotherapy strategy, however, the lack of a unique cancer surface marker poses a challenge. As previously mentioned, CD33 and CD123 are among the most common markers and constitute a potential target for such therapy. There are particularly high hopes for C33 as it is not present on hematopoietic stem cells and GO showed satisfactory outcomes in AML which, taken together, gives a base for more advanced investigations. Lastly, NK cells also represent a promising immunotherapy target, serving several crucial functions in the immune system, enabling the use of universal donors and being related to a lower risk of inducing GVHD. Ongoing clinical trials are aimed at clarifying the design of CAR-T and CAR-NK cells, incorporating multispecific targeting approaches, mitigating treatment-related toxicities, and enhancing strategies to prevent disease relapse [151,156,165,184,185]. Immunotherapeutic approaches and novel drugs [150,165,186,187,188,189] are shown in Figure 4.

Figure 4.
Immunotherapeutic approaches to AML. Created at https://BioRender.com, accessed 16 July 2025.
5. Future Directions
Although various genetic lesions are already part of risk stratification in children with AML, many mutations are yet to be revealed. A new study, using targeted NGS, found a novel recurring mutation in the BCORL1 gene, which was present in 9% of patients at diagnosis. The same study also identified CUX1, KDM6A, PHF6, and STAG2 mutations, whose frequencies were significantly higher than those in similar earlier reports. Such information is crucial for understanding the heterogenous genetic foundation of childhood AML, leading to better molecular characterization and more efficient risk ranking [190].
Hypodiploidy is a risk factor that has not yet been independently analyzed in pediatric AML. It is defined as modal numbers (MNs) of 45 and less and found in nearly 2% of cases. MNs of 43 and 44 are related to unsatisfactory survival outcomes, particularly monosomal karyotype or monosomy 9, whereas an MN below 43 has not been discovered. Hypodiploid AML is described as a rare subgroup that showed unfavorable results, even after HSCT in CR1. Consequently, children from this group should be more precisely assigned to risk groups, due to hypodiploidy being a high-risk factor, and alternative therapies should be explored since those patients might not benefit from conventional strategies [191].
One of the novel diagnostic approaches includes using targeted NGS of circulating tumor DNA (ctDNA), held in circulating free cell DNA (cfDNA) that is released as a result of necrosis or apoptosis of a tumor cell, as a sample for mutation recognition. Studies show that ctDNA not only provides a mirrored image of genomic patterns from bone marrow but there is also a subset of mutations that is discovered only through ctDNA detection. This method is relatively non-invasive and can be complementary to bone marrow biopsy for gathering valid information that can further refine treatment strategies for pediatric AML, however, extended research is still needed [192].
There is an additional marker that has both diagnostic and prognostic capacity, that is, the expression of microRNA-29a (miRNA-29a) and microRNA-100 (miRNA-100). miRNA is an epigenetic controller of regular cell processes, and its malfunction plays a major role in the progression of several pathologies, including hematological malignancies. Two distinct patterns of expression were observed for miRNA-29a and miRNA-100 in a 2022 study by Said et al. Children with AML presented explicitly increased circulation of miRNA-100, when compared to a healthy population, whereas circulation of miRNA-29a was noticeably lower in AML patients. Both markers are said to be predictors of unsatisfactory results after standard therapy, which can be of help when selecting the most suitable treatment strategy [193].
A newly discovered mechanism called cuproptosis impacts AML biology and has a potential to become a prognostic predictor and target for therapy. It is a type of programmed cell death that is prompted by accumulation of intracellular copper ions. Cuproptosis-related genes (CRGs), such as CNN3 and LGR4, are associated with modulation of AML progression, with CNN3 being correlated to unfavorable prognosis, which can be a prospective therapeutic point of interest, along with advancing risk assessment [194].
In the search for a new treatment strategy, in pre-clinical and clinical results, CD74 expression occurred as an encouraging target. CD74, an invariant chain of MHC-II, is associated with promoting antigen presentation, in addition to being part of stem cell maintenance, activation of macrophages and monocytes, as well as T-cell and B-cell function. It has been observed that CD74 expression was significantly higher in several hematopoietic malignancies, including pediatric AML, compared to normal myeloid progenitor cells, making it a potential therapeutic target. Another suggested application is using CD74 in monitoring MRD after therapy. It has also been found that increased CD74 expression is correlated to positive prognostic genetic lesions, and such patients tend to achieve higher EFS, yet still 50% of those patients face adverse events. Despite very promising findings, further data is required to develop more specific utilization of such knowledge [189].
One of the biggest challenges is the fact that pediatric AML is a widely immunophenotypically and biologically heterogenous disease and there are significant differences when compared to adult AML. Thus, more children-focused studies are needed to allow even more precise and adequate risk stratification, along with the choice of optimal treatment strategies [19,195].
6. Case Report
6.1. Medical History and Complaints at Presentation
A 15-month-old male patient with no previous medical history was admitted to the University Children’s Hospital in Lublin with complaints of anuria, accompanied by increased thirst and weakness that started the previous day. According to the parents, the boy experienced profuse sweating, which had been present for about two months.
6.2. Results at Admission
On admission, the patient was in semi-good clinical condition, visibly apathic, with skin pallor and minor petechiae present on lower limbs and lower border of the liver palpable over 3 cm below the costal margin. Initial laboratory tests revealed severe hyperleukocytosis of 166,380 cells/μL, automated peripheral blood count showed 30% neutrophiles, 15.4% lymphocytes, and 53.8% monocytes, plus mild thrombocytopenia with platelet count 92,000 cells/μL. Abdominal ultrasonography was unremarkable. The patient was admitted to the Department of Pediatric Hematology, Oncology and Transplantology with suspected hematological malignancy.
A peripheral blood smear showed about 88% myeloblasts (Figure 5). Because of the elevated WBC count, peripheral blood flow cytometry was performed instead of bone marrow sampling. The cytometric phenotyping showed precursor cells with the following phenotype: CD33 98%, CD117 30%, CD45 88%, CD64 97%, which confirmed the diagnosis of AML M4/M5 according to the former FAB classification.

Figure 5.
Peripheral blood smear findings of the AML case: myeloblasts in the cytoplasm (Wright-Giemsa stain).
6.3. Patient Management During Hospitalization
The patient was treated with pre-phase chemotherapy consisting of cytarabine (1 × 20 mg/m2), followed by ICE (idarubicin 10 mg/m2/day, days 1–3 + cytarabine 200 mg/m2/day in continuous infusion, days 1–7 + etoposide 100 mg/m2/day, days 1–5) for induction treatment.
Hematological remission was achieved after the first induction cycle, twenty-eight days afterwards. BM aspirate revealed 4.2% myeloblasts and 0.003% flow-cytometry-measurable residual disease (FC-MRD). A molecular analysis confirmed the presence of a KMT2A::MLLT1 fusion gene and, on this basis, the patient was then later classified into the AML with KMT2A-rearrangement diagnostic category, according to the 2022 World Health Organization (WHO) Classification of Pediatric Tumors. Cytogenetic analysis using GTG banding revealed a complex karyotype. Metaphase cells from short-term 24 h unstimulated cultures were examined. Bone marrow cytogenetic testing exhibited a complex karyotype described according to the International System of Human Cytogenomic Nomenclature (ISCN) 2020 as 47,XY,del(1)(p32),+8,der(11)t(11;14)(q13;q32),der(14)t(14;11)(q32;q13)t(11;19)(q23;p13),der(19)t(11;19)(q23;p13)[25]. The boy was classified according to the high-risk (HR) Associazione Italiana Ematologia Oncologia Pediatrica-Berlin, Frankfurt, Münster-AML-2020 (AIEOP-BMF-AML-2020) protocol, and treatment was administered according to the AIEOP-BMF-AML-2020 clinical trial group A.
The patient proceeded to receive a second induction chemotherapy course with HAM (cytarabine 3000 mg/m2 every 12 h, days 1–3 + mitoxantrone 10 mg/m2/day, days 3, 4), followed by HAE (cytarabine 3000 mg/m2 every 12 h, days 1–3 + etoposide 125 mg/m2/day, days 2–5) chemotherapy. A second BM aspirate revealed 4.8% myeloblasts and negative FC-MRD < 0.1%.
Following sustained hematological remission, a HAM (cytarabine 1000 mg/m2 every 12 h, days 1–3 + mitoxantrone 10 mg/m2/day, days 3 and 4) chemotherapy course was introduced. Unfortunately, around one month later control BM biopsy revealed 8.4% myeloblasts. A molecular analysis confirmed the presence of the KMT2A::MLLT1 fusion gene and disclosed a positive FC-MRD. Considering the results, a disease relapse was diagnosed.
6.4. Case Approach and Results
The patient received first reinduction therapy, i.e., FLA-GO (fludarabine 30 mg/m2/day, days 1–5 + cytarabine 2000 mg/m2, days 1–5 + GO 4.5 mg/m2, day 4 and 7). Because of the bad treatment tolerance, such as profound BM aplasia leading to sepsis, the therapy was discontinued. Due to the achievement of hematologic remission, the decision was made to forgo the second cycle of FLA-GO treatment and proceed with hematopoietic stem cell transplantation. The patient underwent MUD peripheral blood stem cell transplant (PBSCT) CD34—7 × 106/bw kg, CD3—3.5 × 108/bw kg, preceded by myeloablative conditioning (fludarabine 30 mg/m2, days -7, -6, -5, -4, -3 + treosulfan 10 mg/m2, days -6, -5, -4 + thiotepa 2 × 5 mg/bw kg/day on day -2). Despite initially satisfactory graft success, follow-up bone marrow biopsies performed four months later showed FC-MRD with 16.73% myeloblasts and later 67.9% myeloblasts, revealing a post-transplant relapse of AML.
6.5. Discussion
Cases of coexisting similar genetic aberrations have been described among adults [196,197] and children [198] with AML. A complex karyotype (CK) in AML is defined as having three or more unrelated chromosomal abnormalities [21] in the absence of the WHO recurrent genetic aberrations of t(8;21)(q22;q22), inv(16)(p13.1q22)/t(16;16) (p13.1;q22); t(15;17)(q22;q12); t(9;11)(p22;q23), t(6;9)(p23;q34), inv(3)(q21q26)/t(3;3)(q21;q26), and t(9;22)(q34;q11.2) [199,200,201]. The prevalence of CK-AML varies from 9.5% to 18.5% [202,203]. Moreover, prevalence of CK in the pediatric AML population is age-dependent, with a higher incidence in children below the age of two (20.0%) than in young children and adolescents (10.8%) [202], which is similar to data regarding our patient. Although more research is needed to establish the role of CK in pediatric AML, recent studies show that patients with CK-AML have reduced EFS and OS rates compared with patients with intermediate-risk AML, indicating that CK is an unfavorable risk marker for pediatric AML [202]. However, for patients with a CK-AML and coexisting KMT2A rearrangement, the prognosis seems to be determined by the fusion partner gene rather than the karyotype structure [198].
7. Conclusions
In recent years, our comprehension of the pathophysiology of pediatric AML has expanded significantly. We now know that specific individual and disease-specific factors have predictive value. Although AML is a heterogeneous disease, understanding the underlying genetic background has led to the identification of recurrent genetic abnormalities, which form the basis of current patient risk stratification. Studies of clonal blast evolution are also underway to better understand the nature of disease relapse. All this has led to the development of new approaches, an improved ability to measure small numbers of malignant myeloid cells, and the introduction of targeted therapy with numerous newly approved drugs. Although various genetic lesions are already part of risk stratification in children with AML, many mutations are yet to be revealed. As we enter the era of genome-wide NGS to help us go beyond what is known today about clinically relevant genetic variations, with further implications for classification, prognosis, and therapy, collaboration on data and clinical trials is essential.
Author Contributions
Conceptualization, M.L. (Monika Lejman) and J.Z.; data curation, M.L. (Maria Leśniak), A.S., E.K., P.D., and A.O.; writing—original draft preparation, M.L. (Maria Leśniak), A.S., and E.K.; writing—review and editing, M.L. (Monika Lejman), J.Z., P.D., and A.O.; supervision, M.L. (Monika Lejman), J.Z., P.D., and A.O. All authors have read and agreed to the published version of the manuscript.
Funding
This research received no external funding.
Institutional Review Board Statement
Not applicable.
Informed Consent Statement
Informed consent was obtained from all subjects involved in the study.
Data Availability Statement
The original contributions presented in this study are included in the article. Further inquiries can be directed to the corresponding author(s).
Acknowledgments
During the preparation of this manuscript/study, the author(s) used BioRender, accessed 16 July 2025, and Zotero for the purposes of preparing figures and bibliography. The authors have reviewed and edited the output and take full responsibility for the content of this publication.
Conflicts of Interest
The authors declare no conflicts of interest.
Abbreviations
The following abbreviations are used in this manuscript:
| AML | Acute Myeloid Leukemia |
| ALL | Acute Lymphoblastic Leukemia |
| NGS | Next-Generation Sequencing |
| HRG | High-Risk Group |
| MUD | Matched Unrelated Donor |
| SCT | Stem Cell Transplantation |
| OS | Overall Survival |
| NIH | National Institutes of Health |
| HSCT | Hematopoietic Stem Cell Transplantation |
| WBC | White Blood Cell |
| CNS | Central Nervous System |
| CR | Complete Remission |
| FAB | French–American–British |
| PFS | Progression-Free Survival |
| BM | Bone Marrow |
| EFS | Event-Free Survival |
| BMI | Body Mass Index |
| RFS | Relapse-Free Survival |
| DIC | Disseminated Intravascular Coagulation |
| TLS | Tumor Lysis Syndrome |
| CBF | Core-Binding Factor |
| WES | Whole-Exome Sequencing |
| MRD | Measurable Residual Disease |
| DFS | Disease-Free Survival |
| MPFC | Multiparameter Flow Cytometry |
| qPCR | Quantitative Polymerase Chain Reaction |
| ddPCR | Digital Droplet Polymerase Chain Reaction |
| ELN | European Leukemia Net |
| GO | Gemtuzumab Ozogamicin |
| SMMHC | Smooth Muscle Myosin Heavy Chain |
| NPM1 | Nucleophosmin 1 |
| FLT3-ITD | FLT3-Internal Tandem Duplications |
| FLT3-TKD | FLT3-Tyrosine Kinase Domain |
| allo-HSCT | allogenic HSCT |
| TRM | Treatment-Related Mortality |
| FDA | Food and Drug Administration |
| COG | Children’s Oncology Group |
| HAR | High Allelic Ratio |
| CR1 | First Complete Remission |
| GVL | Graft Versus Leukemia |
| GVHD | Graft-Versus-Host Disease |
| TBI | Total Body Irradiation |
| BuCy | busulfan–cyclophosphamide |
| BuCyMel | busulfan–cyclophosphamide–melphalan |
| CloFluBu | clofarabine–fludarabine–busulfan |
| TDM | Therapeutic Drug Monitoring |
| LFS | Leukemia-Free Survival |
| MAC | Myeloablative Conditioning |
| RIC | Reduced-Intensity Conditioning |
| DLI | Donor Lymphocyte Infusion |
| BCL-2 | B-Cell Leukemia/Lymphoma-2 |
| JM | Juxtamembrane |
| MCL-1 | Myeloid Cell Leukemia 1 |
| BH3 | BCL-2 homology 3 |
| MOMP | Mitochondrial Outer Membrane Permeabilization |
| HMA | Hypomethylating Agent |
| HDAC | Histone Deacetylase |
| HDACi | Histone Deacetylases inhibitor |
| AZA | Azacitidine |
| DEC | Decytabine |
| HATs | Histone Acetyltransferases |
| MHC | Major Histocompatibility Complex |
| NK | Natural Killer |
| CAR-T | Chimeric Antigen Receptor T cell |
| ADCs | Antibody–Drug Conjugates |
| BiTE | Bispecific T-cell Engager |
| DART | Dual-Affinity Retargeting |
| MNs | Modal Numbers |
| ctDNA | Circulating Tumor DNA |
| cfDNA | Circulating Free Cell DNA |
| miRNA-29a | microRNA-29a |
| miRNA-100 | microRNA-100 |
| CRGs | Cuproptosis-Related Genes |
| FC-MRD | Flow-Cytometry-Measurable Residual Disease |
| WHO | World Health Organization |
| ISCN | International System of Human Cytogenomic Nomenclature |
| AIEOP-BMF | Associazione Italiana Ematologia Oncologia Pediatrica-Berlin, Frankfurt, Münster |
| PBSCT | Peripheral Blood Stem Cell Transplantation |
| CK | Complex Karyotype |
References
- Acute Myeloid Leukemia—Cancer Stat Facts. Available online: https://seer.cancer.gov/statfacts/html/amyl.html (accessed on 19 July 2025).
- Rubnitz, J.E.; Kaspers, G.J.L. How I Treat Pediatric Acute Myeloid Leukemia. Blood 2021, 138, 1009–1018. [Google Scholar] [CrossRef]
- Port, M.; Böttcher, M.; Thol, F.; Ganser, A.; Schlenk, R.; Wasem, J.; Neumann, A.; Pouryamout, L. Prognostic Significance of FLT3 Internal Tandem Duplication, Nucleophosmin 1, and CEBPA Gene Mutations for Acute Myeloid Leukemia Patients with Normal Karyotype and Younger than 60 Years: A Systematic Review and Meta-Analysis. Ann. Hematol. 2014, 93, 1279–1286. [Google Scholar] [CrossRef]
- Kuhlen, M.; Klusmann, J.-H.; Hoell, J.I. Molecular Approaches to Treating Pediatric Leukemias. Front. Pediatr. 2019, 7, 368. [Google Scholar] [CrossRef] [PubMed]
- Rasche, M.; Zimmermann, M.; Borschel, L.; Bourquin, J.-P.; Dworzak, M.; Klingebiel, T.; Lehrnbecher, T.; Creutzig, U.; Klusmann, J.-H.; Reinhardt, D. Successes and Challenges in the Treatment of Pediatric Acute Myeloid Leukemia: A Retrospective Analysis of the AML-BFM Trials from 1987 to 2012. Leukemia 2018, 32, 2167–2177. [Google Scholar] [CrossRef]
- Inaba, H.; Mullighan, C.G. Pediatric Acute Lymphoblastic Leukemia. Haematologica 2020, 105, 2524–2539. [Google Scholar] [CrossRef]
- Kaplan, J.A. Leukemia in Children. Pediatr. Rev. 2019, 40, 319–331. [Google Scholar] [CrossRef]
- Döhner, H.; Wei, A.H.; Appelbaum, F.R.; Craddock, C.; DiNardo, C.D.; Dombret, H.; Ebert, B.L.; Fenaux, P.; Godley, L.A.; Hasserjian, R.P.; et al. Diagnosis and Management of AML in Adults: 2022 Recommendations from an International Expert Panel on Behalf of the ELN. Blood 2022, 140, 1345–1377. [Google Scholar] [CrossRef]
- National Childhood Cancer Registry Explorer (NCCR*Explorer). Available online: https://nccrexplorer.ccdi.cancer.gov/ (accessed on 19 July 2025).
- De Rooij, J.D.E.; Zwaan, C.M.; Van den Heuvel-Eibrink, M. Pediatric AML: From Biology to Clinical Management. J. Clin. Med. 2015, 4, 127–149. [Google Scholar] [CrossRef] [PubMed]
- Tarlock, K.; Meshinchi, S. Pediatric Acute Myeloid Leukemia: Biology and Therapeutic Implications of Genomic Variants. Pediatr. Clin. N. Am. 2015, 62, 75–93. [Google Scholar] [CrossRef]
- Tomizawa, D.; Tsujimoto, S.-I. Risk-Stratified Therapy for Pediatric Acute Myeloid Leukemia. Cancers 2023, 15, 4171. [Google Scholar] [CrossRef]
- Arber, D.A.; Orazi, A.; Hasserjian, R.P.; Borowitz, M.J.; Calvo, K.R.; Kvasnicka, H.-M.; Wang, S.A.; Bagg, A.; Barbui, T.; Branford, S.; et al. International Consensus Classification of Myeloid Neoplasms and Acute Leukemias: Integrating Morphologic, Clinical, and Genomic Data. Blood 2022, 140, 1200–1228. [Google Scholar] [CrossRef]
- Mustafa, O.; Abdalla, K.; AlAzmi, A.A.; Elimam, N.; Abrar, M.B.; Jastaniah, W. FLAG/FLAG-IDA Regimen for Children with Relapsed/Refractory Acute Leukemia in the Era of Targeted Novel Therapies. J. Oncol. Pharm. Pract. 2019, 25, 1831–1838. [Google Scholar] [CrossRef]
- Kaspers, G. How I Treat Paediatric Relapsed Acute Myeloid Leukaemia. Br. J. Haematol. 2014, 166, 636–645. [Google Scholar] [CrossRef]
- Jongen-Lavrencic, M.; Grob, T.; Hanekamp, D.; Kavelaars, F.G.; Al Hinai, A.; Zeilemaker, A.; Erpelinck-Verschueren, C.A.J.; Gradowska, P.L.; Meijer, R.; Cloos, J.; et al. Molecular Minimal Residual Disease in Acute Myeloid Leukemia. N. Engl. J. Med. 2018, 378, 1189–1199. [Google Scholar] [CrossRef]
- Bertuccio, S.N.; Anselmi, L.; Masetti, R.; Lonetti, A.; Cerasi, S.; Polidori, S.; Serravalle, S.; Pession, A. Exploiting Clonal Evolution to Improve the Diagnosis and Treatment Efficacy Prediction in Pediatric AML. Cancers 2021, 13, 1995. [Google Scholar] [CrossRef] [PubMed]
- Pommert, L.; Tarlock, K. The Evolution of Targeted Therapy in Pediatric AML: Gemtuzumab Ozogamicin, FLT3/IDH/BCL2 Inhibitors, and Other Therapies. Hematol. Am. Soc. Hematol. Educ. Program 2022, 2022, 603–610. [Google Scholar] [CrossRef]
- Ciciarello, M.; Corradi, G.; Forte, D.; Cavo, M.; Curti, A. Emerging Bone Marrow Microenvironment-Driven Mechanisms of Drug Resistance in Acute Myeloid Leukemia: Tangle or Chance? Cancers 2021, 13, 5319. [Google Scholar] [CrossRef] [PubMed]
- Noviello, M.; Manfredi, F.; Ruggiero, E.; Perini, T.; Oliveira, G.; Cortesi, F.; De Simone, P.; Toffalori, C.; Gambacorta, V.; Greco, R.; et al. Bone Marrow Central Memory and Memory Stem T-Cell Exhaustion in AML Patients Relapsing after HSCT. Nat. Commun. 2019, 10, 1065. [Google Scholar] [CrossRef] [PubMed]
- Döhner, H.; Estey, E.; Grimwade, D.; Amadori, S.; Appelbaum, F.R.; Büchner, T.; Dombret, H.; Ebert, B.L.; Fenaux, P.; Larson, R.A.; et al. Diagnosis and Management of AML in Adults: 2017 ELN Recommendations from an International Expert Panel. Blood 2017, 129, 424–447. [Google Scholar] [CrossRef]
- Liu, S.; Hu, B.; Zhang, J. Epidemiological Characteristics and Influencing Factors of Acute Leukemia in Children and Adolescents and Adults: A Large Population-Based Study. Hematology 2024, 29, 2327916. [Google Scholar] [CrossRef]
- Hossain, M.J.; Xie, L.; Caywood, E.H. Prognostic Factors of Childhood and Adolescent Acute Myeloid Leukemia (AML) Survival: Evidence from Four Decades of US Population Data. Cancer Epidemiol. 2015, 39, 720–726. [Google Scholar] [CrossRef] [PubMed]
- Løhmann, D.J.A.; Abrahamsson, J.; Ha, S.-Y.; Jónsson, Ó.G.; Koskenvuo, M.; Lausen, B.; Palle, J.; Zeller, B.; Hasle, H. Effect of Age and Body Weight on Toxicity and Survival in Pediatric Acute Myeloid Leukemia: Results from NOPHO-AML 2004. Haematologica 2016, 101, 1359–1367. [Google Scholar] [CrossRef]
- Wang, Y.; Huang, J.; Rong, L.; Wu, P.; Kang, M.; Zhang, X.; Lu, Q.; Fang, Y. Impact of Age on the Survival of Pediatric Leukemia: An Analysis of 15083 Children in the SEER Database. Oncotarget 2016, 7, 83767–83774. [Google Scholar] [CrossRef]
- Blais, S.; Boutroux, H.; Pasquet, M.; Leblanc, T.; Fenneteau, O.; Gandemer, V.; Bertrand, Y.; Ducassou, S.; Michel, G.; Nelken, B.; et al. Is Acute Myeloblastic Leukemia in Children Under 2 Years of Age a Specific Entity? A Report from the FRENCH ELAM02 Study Group. Hemasphere 2019, 3, e316. [Google Scholar] [CrossRef]
- Hara, Y.; Shiba, N.; Yamato, G.; Ohki, K.; Tabuchi, K.; Sotomatsu, M.; Tomizawa, D.; Kinoshita, A.; Arakawa, H.; Saito, A.M.; et al. Patients Aged Less than 3 Years with Acute Myeloid Leukaemia Characterize a Molecularly and Clinically Distinct Subgroup. Br. J. Haematol. 2020, 188, 528–539. [Google Scholar] [CrossRef] [PubMed]
- Pawińska-Wąsikowska, K.; Czogała, M.; Bukowska-Strakova, K.; Surman, M.; Rygielska, M.; Książek, T.; Sadowska, B.; Pac, A.; Skalska-Sadowska, J.; Samborska, M.; et al. Treatment Outcomes of Adolescents Compared to Younger Pediatric Patients with Acute Myeloid Leukemia: Do They Need a Special Approach? Cancers 2024, 16, 1145. [Google Scholar] [CrossRef] [PubMed]
- O’Dwyer, K.; Freyer, D.R.; Horan, J.T. Treatment Strategies for Adolescent and Young Adult Patients with Acute Myeloid Leukemia. Blood 2018, 132, 362–368. [Google Scholar] [CrossRef]
- Liu, L.-P.; Zhang, A.-L.; Ruan, M.; Chang, L.-X.; Liu, F.; Chen, X.; Qi, B.-Q.; Zhang, L.; Zou, Y.; Chen, Y.-M.; et al. Prognostic Stratification of Molecularly and Clinically Distinct Subgroup in Children with Acute Monocytic Leukemia. Cancer Med. 2020, 9, 3647–3655. [Google Scholar] [CrossRef]
- Conneely, S.E.; McAtee, C.L.; Gupta, R.; Lubega, J.; Scheurer, M.E.; Rau, R.E. Association of Race and Ethnicity with Clinical Phenotype, Genetics, and Survival in Pediatric Acute Myeloid Leukemia. Blood Adv. 2021, 5, 4992–5001. [Google Scholar] [CrossRef]
- Bhatnagar, B.; Kohlschmidt, J.; Mrózek, K.; Zhao, Q.; Fisher, J.L.; Nicolet, D.; Walker, C.J.; Mims, A.S.; Oakes, C.; Giacopelli, B.; et al. Poor Survival and Differential Impact of Genetic Features of Black Patients with Acute Myeloid Leukemia. Cancer Discov. 2021, 11, 626–637. [Google Scholar] [CrossRef]
- Larkin, K.T.; Nicolet, D.; Kelly, B.J.; Mrózek, K.; LaHaye, S.; Miller, K.E.; Wijeratne, S.; Wheeler, G.; Kohlschmidt, J.; Blachly, J.S.; et al. High Early Death Rates, Treatment Resistance, and Short Survival of Black Adolescents and Young Adults with AML. Blood Adv. 2022, 6, 5570–5581. [Google Scholar] [CrossRef] [PubMed]
- Li, Y.; Newton, J.G.; Getz, K.D.; Huang, Y.-S.; Seif, A.E.; Fisher, B.T.; Aplenc, R.; Winestone, L.E. Comparable On-Therapy Mortality and Supportive Care Requirements in Black and White Patients Following Initial Induction for Pediatric Acute Myeloid Leukemia. Pediatr. Blood Cancer 2019, 66, e27583. [Google Scholar] [CrossRef] [PubMed]
- Winestone, L.E.; Getz, K.D.; Rao, P.; Li, Y.; Hall, M.; Huang, Y.-S.V.; Seif, A.E.; Fisher, B.T.; Aplenc, R. Disparities in Pediatric Acute Myeloid Leukemia (AML) Clinical Trial Enrollment. Leuk. Lymphoma 2019, 60, 2190–2198. [Google Scholar] [CrossRef]
- Lamba, J.K.; Marrero, R.; Wu, H.; Cao, X.; Parcha, P.K.; Karol, S.E.; Inaba, H.; Kuo, D.J.; Degar, B.A.; Heym, K.; et al. Pharmacogenomics, Race, and Treatment Outcome in Pediatric Acute Myeloid Leukemia. JAMA Netw. Open 2024, 7, e2411726. [Google Scholar] [CrossRef]
- Hu, W.; Cheung, Y.T.; Tang, Y.; Hong, L.; Zhu, Y.; Chen, J.; Wang, Z.; Zhou, M.; Gao, Y.; Chen, J.; et al. Association Between Body Mass Index at Diagnosis and Outcomes in Chinese Children with Newly Diagnosed Acute Lymphoblastic Leukemia. Cancer Med. 2023, 12, 2850–2860. [Google Scholar] [CrossRef]
- Wadhwa, A.; Chen, Y.; Hageman, L.; Hoppmann, A.L.; Angiolillo, A.; Dickens, D.S.; Lew, G.; Neglia, J.P.; Ravindranath, Y.; Ritchey, A.K.; et al. Body Mass Index during Maintenance Therapy and Relapse Risk in Children with Acute Lymphoblastic Leukemia: A Children’s Oncology Group Report. Cancer 2023, 129, 151–160. [Google Scholar] [CrossRef]
- Inaba, H.; Surprise, H.C.; Pounds, S.; Cao, X.; Howard, S.C.; Ringwald-Smith, K.; Buaboonnam, J.; Dahl, G.; Bowman, W.P.; Taub, J.W.; et al. Effect of Body Mass Index on the Outcome of Children with Acute Myeloid Leukemia. Cancer 2012, 118, 5989–5996. [Google Scholar] [CrossRef]
- Iijima, M.; Stall, M.; Wang, L.; Panetta, J.C.; Triplett, B.M.; Pui, C.-H.; Ribeiro, R.C.; Rubnitz, J.E.; Pounds, S.B.; Inaba, H. Changes in Body Mass Index, Weight, and Height in Children with Acute Myeloid Leukemia and the Associations with Outcome. Blood Adv. 2022, 6, 2824–2834. [Google Scholar] [CrossRef]
- Wen, X.; He, H.; Zhang, R.; Wu, Y.; Zhang, Y.; Lin, W.; Yu, J.; Fan, J.; Huang, P.; Chen, J.; et al. Longitudinal Changes in Body Mass Index, Height, and Weight in Children with Acute Myeloid Leukemia. BMC Pediatr. 2024, 24, 293. [Google Scholar] [CrossRef]
- Dong, L.; Dai, G.; Zhao, J. Impact of Body Mass Index at Diagnosis on Outcomes of Pediatric Acute Leukemia: A Systematic Review and Meta-Analysis. PLoS ONE 2024, 19, e0302879. [Google Scholar] [CrossRef] [PubMed]
- Khoury, J.D.; Solary, E.; Abla, O.; Akkari, Y.; Alaggio, R.; Apperley, J.F.; Bejar, R.; Berti, E.; Busque, L.; Chan, J.K.C.; et al. The 5th Edition of the World Health Organization Classification of Haematolymphoid Tumours: Myeloid and Histiocytic/Dendritic Neoplasms. Leukemia 2022, 36, 1703–1719. [Google Scholar] [CrossRef]
- Shimada, A. Profile of down Syndrome–Associated Malignancies: Epidemiology, Clinical Features and Therapeutic Aspects. Pediatr. Hematol. Oncol. J. 2021, 6, 63–72. [Google Scholar] [CrossRef]
- Triarico, S.; Trombatore, G.; Capozza, M.A.; Romano, A.; Mastrangelo, S.; Attinà, G.; Maurizi, P.; Ruggiero, A. Hematological Disorders in Children with Down Syndrome. Expert Rev. Hematol. 2022, 15, 127–135. [Google Scholar] [CrossRef]
- Kosmidou, A.; Tragiannidis, A.; Gavriilaki, E. Myeloid Leukemia of Down Syndrome. Cancers 2023, 15, 3265. [Google Scholar] [CrossRef] [PubMed]
- Risitano, A.M.; Marotta, S.; Calzone, R.; Grimaldi, F.; Zatterale, A.; RIAF Contributors. Twenty Years of the Italian Fanconi Anemia Registry: Where We Stand and What Remains to Be Learned. Haematologica 2016, 101, 319–327. [Google Scholar] [CrossRef]
- Rama, H.; Gupta, D.; Chatterjee, T.; Gupta, S. Fanconi Anemia with MDS RAEB-2 Rapidly Progressing to AML in a 5-Year-Old Boy. Indian J. Hematol. Blood Transfus. 2014, 30, 379–382. [Google Scholar] [CrossRef] [PubMed][Green Version]
- Poppe, B.; Van Limbergen, H.; Van Roy, N.; Vandecruys, E.; De Paepe, A.; Benoit, Y.; Speleman, F. Chromosomal Aberrations in Bloom Syndrome Patients with Myeloid Malignancies. Cancer Genet. Cytogenet. 2001, 128, 39–42. [Google Scholar] [CrossRef]
- Dror, Y.; Freedman, M.H. Shwachman-Diamond Syndrome. Br. J. Haematol. 2002, 118, 701–713. [Google Scholar] [CrossRef] [PubMed]
- Jongmans, M.C.J.; van der Burgt, I.; Hoogerbrugge, P.M.; Noordam, K.; Yntema, H.G.; Nillesen, W.M.; Kuiper, R.P.; Ligtenberg, M.J.L.; van Kessel, A.G.; van Krieken, J.H.J.M.; et al. Cancer Risk in Patients with Noonan Syndrome Carrying a PTPN11 Mutation. Eur. J. Hum. Genet. 2011, 19, 870–874. [Google Scholar] [CrossRef]
- Sahoo, S.S.; Kozyra, E.J.; Wlodarski, M.W. Germline Predisposition in Myeloid Neoplasms: Unique Genetic and Clinical Features of GATA2 Deficiency and SAMD9/SAMD9L Syndromes. Best Pract. Res. Clin. Haematol. 2020, 33, 101197. [Google Scholar] [CrossRef]
- Smith, M.L.; Cavenagh, J.D.; Lister, T.A.; Fitzgibbon, J. Mutation of CEBPA in Familial Acute Myeloid Leukemia. N. Engl. J. Med. 2004, 351, 2403–2407. [Google Scholar] [CrossRef]
- Pathak, A.; Seipel, K.; Pemov, A.; Dewan, R.; Brown, C.; Ravichandran, S.; Luke, B.T.; Malasky, M.; Suman, S.; Yeager, M.; et al. Whole Exome Sequencing Reveals a C-Terminal Germline Variant in CEBPA-Associated Acute Myeloid Leukemia: 45-Year Follow up of a Large Family. Haematologica 2016, 101, 846–852. [Google Scholar] [CrossRef]
- Mendoza, H.; Chen, P.-H.; Pine, A.B.; Siddon, A.J.; Bale, A.E.; Gowda, L.; Killie, A.; Richards, J.; Varin-Tremblay, C.; Kloss, R.; et al. A Case of Acute Myeloid Leukemia with Unusual Germline CEBPA Mutation: Lessons Learned about Mutation Detection, Location, and Penetrance. Leuk. Lymphoma 2021, 62, 1251–1254. [Google Scholar] [CrossRef]
- Tawana, K.; Rio-Machin, A.; Preudhomme, C.; Fitzgibbon, J. Familial CEBPA-Mutated Acute Myeloid Leukemia. Semin. Hematol. 2017, 54, 87–93. [Google Scholar] [CrossRef]
- Harrigan, A.M.; Trottier, A.M. Hereditary Acute Myeloid Leukemia Associated with C-Terminal CEBPA Germline Variants. Fam. Cancer 2023, 22, 331–339. [Google Scholar] [CrossRef]
- Brown, A.L.; Hahn, C.N.; Scott, H.S. Secondary Leukemia in Patients with Germline Transcription Factor Mutations (RUNX1, GATA2, CEBPA). Blood 2020, 136, 24–35. [Google Scholar] [CrossRef] [PubMed]
- Hahn, C.N.; Chong, C.-E.; Carmichael, C.L.; Wilkins, E.J.; Brautigan, P.J.; Li, X.-C.; Babic, M.; Lin, M.; Carmagnac, A.; Lee, Y.K.; et al. Heritable GATA2 Mutations Associated with Familial Myelodysplastic Syndrome and Acute Myeloid Leukemia. Nat. Genet. 2011, 43, 1012–1017. [Google Scholar] [CrossRef]
- Homan, C.C.; Venugopal, P.; Arts, P.; Shahrin, N.H.; Feurstein, S.; Rawlings, L.; Lawrence, D.M.; Andrews, J.; King-Smith, S.L.; Harvey, N.L.; et al. GATA2 Deficiency Syndrome: A Decade of Discovery. Hum. Mutat. 2021, 42, 1399–1421. [Google Scholar] [CrossRef] [PubMed]
- Al Seraihi, A.F.; Rio-Machin, A.; Tawana, K.; Bödör, C.; Wang, J.; Nagano, A.; Heward, J.A.; Iqbal, S.; Best, S.; Lea, N.; et al. GATA2 Monoallelic Expression Underlies Reduced Penetrance in Inherited GATA2-Mutated MDS/AML. Leukemia 2018, 32, 2502–2507. [Google Scholar] [CrossRef] [PubMed]
- Zhang, M.Y.; Churpek, J.E.; Keel, S.B.; Walsh, T.; Lee, M.K.; Loeb, K.R.; Gulsuner, S.; Pritchard, C.C.; Sanchez-Bonilla, M.; Delrow, J.J.; et al. Germline ETV6 Mutations in Familial Thrombocytopenia and Hematologic Malignancy. Nat. Genet. 2015, 47, 180–185. [Google Scholar] [CrossRef]
- Feurstein, S.; Godley, L.A. Germline ETV6 Mutations and Predisposition to Hematological Malignancies. Int. J. Hematol. 2017, 106, 189–195. [Google Scholar] [CrossRef]
- Bejar, R.; Stevenson, K.; Abdel-Wahab, O.; Galili, N.; Nilsson, B.; Garcia-Manero, G.; Kantarjian, H.; Raza, A.; Levine, R.L.; Neuberg, D.; et al. Clinical Effect of Point Mutations in Myelodysplastic Syndromes. N. Engl. J. Med. 2011, 364, 2496–2506. [Google Scholar] [CrossRef] [PubMed]
- Zhang, J.; Ding, L.; Holmfeldt, L.; Wu, G.; Heatley, S.L.; Payne-Turner, D.; Easton, J.; Chen, X.; Wang, J.; Rusch, M.; et al. The Genetic Basis of Early T-Cell Precursor Acute Lymphoblastic Leukaemia. Nature 2012, 481, 157–163. [Google Scholar] [CrossRef] [PubMed]
- Van Vlierberghe, P.; Ambesi-Impiombato, A.; Perez-Garcia, A.; Haydu, J.E.; Rigo, I.; Hadler, M.; Tosello, V.; Della Gatta, G.; Paietta, E.; Racevskis, J.; et al. ETV6 Mutations in Early Immature Human T Cell Leukemias. J. Exp. Med. 2011, 208, 2571–2579. [Google Scholar] [CrossRef]
- Noetzli, L.; Lo, R.W.; Lee-Sherick, A.B.; Callaghan, M.; Noris, P.; Savoia, A.; Rajpurkar, M.; Jones, K.; Gowan, K.; Balduini, C.; et al. Germline Mutations in ETV6 Are Associated with Thrombocytopenia, Red Cell Macrocytosis and Predisposition to Lymphoblastic Leukemia. Nat. Genet. 2015, 47, 535–538. [Google Scholar] [CrossRef] [PubMed]
- Moriyama, T.; Metzger, M.L.; Wu, G.; Nishii, R.; Qian, M.; Devidas, M.; Yang, W.; Cheng, C.; Cao, X.; Quinn, E.; et al. Germline Genetic Variation in ETV6 and Risk of Childhood Acute Lymphoblastic Leukaemia: A Systematic Genetic Study. Lancet Oncol. 2015, 16, 1659–1666. [Google Scholar] [CrossRef]
- Jongmans, M.C.J.; Kuiper, R.P.; Carmichael, C.L.; Wilkins, E.J.; Dors, N.; Carmagnac, A.; Schouten-van Meeteren, A.Y.N.; Li, X.; Stankovic, M.; Kamping, E.; et al. Novel RUNX1 Mutations in Familial Platelet Disorder with Enhanced Risk for Acute Myeloid Leukemia: Clues for Improved Identification of the FPD/AML Syndrome. Leukemia 2010, 24, 242–246. [Google Scholar] [CrossRef]
- Preudhomme, C.; Renneville, A.; Bourdon, V.; Philippe, N.; Roche-Lestienne, C.; Boissel, N.; Dhedin, N.; André, J.-M.; Cornillet-Lefebvre, P.; Baruchel, A.; et al. High Frequency of RUNX1 Biallelic Alteration in Acute Myeloid Leukemia Secondary to Familial Platelet Disorder. Blood 2009, 113, 5583–5587. [Google Scholar] [CrossRef]
- Brown, A.L.; Arts, P.; Carmichael, C.L.; Babic, M.; Dobbins, J.; Chong, C.-E.; Schreiber, A.W.; Feng, J.; Phillips, K.; Wang, P.P.S.; et al. RUNX1-Mutated Families Show Phenotype Heterogeneity and a Somatic Mutation Profile Unique to Germline Predisposed AML. Blood Adv. 2020, 4, 1131–1144. [Google Scholar] [CrossRef]
- Luo, X.; Feurstein, S.; Mohan, S.; Porter, C.C.; Jackson, S.A.; Keel, S.; Chicka, M.; Brown, A.L.; Kesserwan, C.; Agarwal, A.; et al. ClinGen Myeloid Malignancy Variant Curation Expert Panel Recommendations for Germline RUNX1 Variants. Blood Adv. 2019, 3, 2962–2979. [Google Scholar] [CrossRef]
- Homan, C.C.; King-Smith, S.L.; Lawrence, D.M.; Arts, P.; Feng, J.; Andrews, J.; Armstrong, M.; Ha, T.; Dobbins, J.; Drazer, M.W.; et al. The RUNX1 Database (RUNX1db): Establishment of an Expert Curated RUNX1 Registry and Genomics Database as a Public Resource for Familial Platelet Disorder with Myeloid Malignancy. Haematologica 2021, 106, 3004–3007. [Google Scholar] [CrossRef] [PubMed]
- Förster, A.; Decker, M.; Schlegelberger, B.; Ripperger, T. Beyond Pathogenic RUNX1 Germline Variants: The Spectrum of Somatic Alterations in RUNX1-Familial Platelet Disorder with Predisposition to Hematologic Malignancies. Cancers 2022, 14, 3431. [Google Scholar] [CrossRef]
- Rafei, H.; DiNardo, C.D. Hereditary Myeloid Malignancies. Best Pract. Res. Clin. Haematol. 2019, 32, 163–176. [Google Scholar] [CrossRef]
- Noris, P.; Perrotta, S.; Seri, M.; Pecci, A.; Gnan, C.; Loffredo, G.; Pujol-Moix, N.; Zecca, M.; Scognamiglio, F.; De Rocco, D.; et al. Mutations in ANKRD26 Are Responsible for a Frequent Form of Inherited Thrombocytopenia: Analysis of 78 Patients from 21 Families. Blood 2011, 117, 6673–6680. [Google Scholar] [CrossRef]
- Pippucci, T.; Savoia, A.; Perrotta, S.; Pujol-Moix, N.; Noris, P.; Castegnaro, G.; Pecci, A.; Gnan, C.; Punzo, F.; Marconi, C.; et al. Mutations in the 5′ UTR of ANKRD26, the Ankirin Repeat Domain 26 Gene, Cause an Autosomal-Dominant Form of Inherited Thrombocytopenia, THC2. Am. J. Hum. Genet. 2011, 88, 115–120. [Google Scholar] [CrossRef]
- Boutroux, H.; Petit, A.; Auvrignon, A.; Lapillonne, H.; Ballerini, P.; Favier, R.; Leverger, G. Childhood Diagnosis of Genetic Thrombocytopenia with Mutation in the Ankyrine Repeat Domain 26 Gene. Eur. J. Pediatr. 2015, 174, 1399–1403. [Google Scholar] [CrossRef]
- Bougeard, G.; Renaux-Petel, M.; Flaman, J.-M.; Charbonnier, C.; Fermey, P.; Belotti, M.; Gauthier-Villars, M.; Stoppa-Lyonnet, D.; Consolino, E.; Brugières, L.; et al. Revisiting Li-Fraumeni Syndrome from TP53 Mutation Carriers. J. Clin. Oncol. 2015, 33, 2345–2352. [Google Scholar] [CrossRef] [PubMed]
- Shin, S.J.; Dodd-Eaton, E.B.; Peng, G.; Bojadzieva, J.; Chen, J.; Amos, C.I.; Frone, M.N.; Khincha, P.P.; Mai, P.L.; Savage, S.A.; et al. Penetrance of Different Cancer Types in Families with Li-Fraumeni Syndrome: A Validation Study Using Multicenter Cohorts. Cancer Res. 2020, 80, 354–360. [Google Scholar] [CrossRef]
- Frebourg, T.; Bajalica Lagercrantz, S.; Oliveira, C.; Magenheim, R.; Evans, D.G.; European Reference Network GENTURIS. Guidelines for the Li-Fraumeni and Heritable TP53-Related Cancer Syndromes. Eur. J. Hum. Genet. 2020, 28, 1379–1386. [Google Scholar] [CrossRef]
- Winter, G.; Kirschner-Schwabe, R.; Groeneveld-Krentz, S.; Escherich, G.; Möricke, A.; von Stackelberg, A.; Stanulla, M.; Bailey, S.; Richter, L.; Steinemann, D.; et al. Clinical and Genetic Characteristics of Children with Acute Lymphoblastic Leukemia and Li-Fraumeni Syndrome. Leukemia 2021, 35, 1475–1479. [Google Scholar] [CrossRef] [PubMed]
- Swaminathan, M.; Bannon, S.A.; Routbort, M.; Naqvi, K.; Kadia, T.M.; Takahashi, K.; Alvarado, Y.; Ravandi-Kashani, F.; Patel, K.P.; Champlin, R.; et al. Hematologic Malignancies and Li-Fraumeni Syndrome. Cold Spring Harb. Mol. Case Stud. 2019, 5, a003210. [Google Scholar] [CrossRef] [PubMed]
- Yoshida, M.; Tanase-Nakao, K.; Shima, H.; Shirai, R.; Yoshida, K.; Osumi, T.; Deguchi, T.; Mori, M.; Arakawa, Y.; Takagi, M.; et al. Prevalence of Germline GATA2 and SAMD9/9L Variants in Paediatric Haematological Disorders with Monosomy 7. Br. J. Haematol. 2020, 191, 835–843. [Google Scholar] [CrossRef]
- Narumi, S.; Amano, N.; Ishii, T.; Katsumata, N.; Muroya, K.; Adachi, M.; Toyoshima, K.; Tanaka, Y.; Fukuzawa, R.; Miyako, K.; et al. SAMD9 Mutations Cause a Novel Multisystem Disorder, MIRAGE Syndrome, and Are Associated with Loss of Chromosome 7. Nat Genet 2016, 48, 792–797. [Google Scholar] [CrossRef] [PubMed]
- Davidsson, J.; Puschmann, A.; Tedgård, U.; Bryder, D.; Nilsson, L.; Cammenga, J. SAMD9 and SAMD9L in Inherited Predisposition to Ataxia, Pancytopenia, and Myeloid Malignancies. Leukemia 2018, 32, 1106–1115. [Google Scholar] [CrossRef]
- Wong, J.C.; Bryant, V.; Lamprecht, T.; Ma, J.; Walsh, M.; Schwartz, J.; Del Pilar Alzamora, M.; Mullighan, C.G.; Loh, M.L.; Ribeiro, R.; et al. Germline SAMD9 and SAMD9L mutations are associated with extensive genetic evolution and diverse hematologic outcomes. JCI Insight. 2018, 3, e121086. [Google Scholar] [CrossRef] [PubMed] [PubMed Central]
- Chabot-Richards, D.S.; George, T.I. Leukocytosis. Int. J. Lab. Hematol. 2014, 36, 279–288. [Google Scholar] [CrossRef]
- Kittivisuit, S.; Jongthitinon, N.; Sripornsawan, P.; Songthawee, N.; Chavananon, S.; Limratchapong, C.; McNeil, E.B.; Chotsampancharoen, T. Hyperleukocytosis in Childhood Acute Leukemia: Early Complications and Survival Outcomes. Cancers 2023, 15, 3072. [Google Scholar] [CrossRef]
- Zhang, A.; Liu, L.; Zong, S.; Chang, L.; Chen, X.; Yang, W.; Guo, Y.; Zhang, L.; Zou, Y.; Chen, Y.; et al. Pediatric Acute Myeloid Leukemia and Hyperleukocytosis with WBC Count Greater than 50 × 109/L. Int. J. Hematol. 2023, 118, 737–744. [Google Scholar] [CrossRef]
- Bonaventure, A.; Harewood, R.; Stiller, C.A.; Gatta, G.; Clavel, J.; Stefan, D.C.; Carreira, H.; Spika, D.; Marcos-Gragera, R.; Peris-Bonet, R.; et al. Worldwide Comparison of Survival from Childhood Leukaemia for 1995-2009, by Subtype, Age, and Sex (CONCORD-2): A Population-Based Study of Individual Data for 89 828 Children from 198 Registries in 53 Countries. Lancet Haematol. 2017, 4, e202–e217, Erratum in Lancet Haematol. 2017, 4, e201. [Google Scholar] [CrossRef] [PubMed]
- Bewersdorf, J.P.; Zeidan, A.M. Hyperleukocytosis and Leukostasis in Acute Myeloid Leukemia: Can a Better Understanding of the Underlying Molecular Pathophysiology Lead to Novel Treatments? Cells 2020, 9, 2310. [Google Scholar] [CrossRef]
- Xu, L.-H.; Wang, J.-W.; Wang, Y.; Yang, F.-Y. Hyperleukocytosis Predicts Inferior Clinical Outcome in Pediatric Acute Myeloid Leukemia. Hematology 2020, 25, 507–514. [Google Scholar] [CrossRef]
- Meshinchi, S.; Arceci, R.J. Prognostic Factors and Risk-Based Therapy in Pediatric Acute Myeloid Leukemia. Oncologist 2007, 12, 341–355. [Google Scholar] [CrossRef]
- Stankiewicz, J.; Demidowicz, E.; Bartoszewicz, N.; Kołtan, A.; Kołtan, S.; Czyżewski, K.; Richert-Przygońska, M.; Dębski, R.; Pogorzała, M.; Tejza, B.; et al. Relapsed Childhood Acute Myeloid Leukemia: Prognostic Factors and Outcomes: Experience from a Single Oncology Center. Acta Haematol. Pol. 2023, 54, 214–220. [Google Scholar] [CrossRef]
- Masetti, R.; Vendemini, F.; Zama, D.; Biagi, C.; Gasperini, P.; Pession, A. All-Trans Retinoic Acid in the Treatment of Pediatric Acute Promyelocytic Leukemia. Expert Rev. Anticancer Ther. 2012, 12, 1191–1204. [Google Scholar] [CrossRef]
- Harrison, C.J.; Hills, R.K.; Moorman, A.V.; Grimwade, D.J.; Hann, I.; Webb, D.K.H.; Wheatley, K.; de Graaf, S.S.N.; van den Berg, E.; Burnett, A.K.; et al. Cytogenetics of Childhood Acute Myeloid Leukemia: United Kingdom Medical Research Council Treatment Trials AML 10 and 12. J. Clin. Oncol. 2010, 28, 2674–2681. [Google Scholar] [CrossRef]
- Conneely, S.E.; Rau, R.E. The Genomics of Acute Myeloid Leukemia in Children. Cancer Metastasis Rev. 2020, 39, 189–209. [Google Scholar] [CrossRef]
- Masetti, R.; Bertuccio, S.N.; Astolfi, A.; Chiarini, F.; Lonetti, A.; Indio, V.; De Luca, M.; Bandini, J.; Serravalle, S.; Franzoni, M.; et al. Hh/Gli Antagonist in Acute Myeloid Leukemia with CBFA2T3-GLIS2 Fusion Gene. J. Hematol. Oncol. 2017, 10, 26. [Google Scholar] [CrossRef]
- Bolouri, H.; Farrar, J.E.; Triche, T.; Ries, R.E.; Lim, E.L.; Alonzo, T.A.; Ma, Y.; Moore, R.; Mungall, A.J.; Marra, M.A.; et al. The Molecular Landscape of Pediatric Acute Myeloid Leukemia Reveals Recurrent Structural Alterations and Age-Specific Mutational Interactions. Nat. Med. 2018, 24, 103–112, Erratum in Nat. Med. 2018, 24, 526; Erratum in Nat. Med. 2019, 25, 530. [Google Scholar] [CrossRef] [PubMed]
- Creutzig, U.; Zimmermann, M.; Reinhardt, D.; Rasche, M.; von Neuhoff, C.; Alpermann, T.; Dworzak, M.; Perglerová, K.; Zemanova, Z.; Tchinda, J.; et al. Changes in Cytogenetics and Molecular Genetics in Acute Myeloid Leukemia from Childhood to Adult Age Groups. Cancer 2016, 122, 3821–3830. [Google Scholar] [CrossRef]
- Masetti, R.; Bertuccio, S.N.; Guidi, V.; Cerasi, S.; Lonetti, A.; Pession, A. Uncommon Cytogenetic Abnormalities Identifying High-Risk Acute Myeloid Leukemia in Children. Future Oncol. 2020, 16, 2747–2762. [Google Scholar] [CrossRef] [PubMed]
- Li, S.; Garrett-Bakelman, F.E.; Chung, S.S.; Sanders, M.A.; Hricik, T.; Rapaport, F.; Patel, J.; Dillon, R.; Vijay, P.; Brown, A.L.; et al. Distinct Evolution and Dynamics of Epigenetic and Genetic Heterogeneity in Acute Myeloid Leukemia. Nat. Med. 2016, 22, 792–799. [Google Scholar] [CrossRef]
- Vosberg, S.; Greif, P.A. Clonal Evolution of Acute Myeloid Leukemia from Diagnosis to Relapse. Genes Chromosomes Cancer 2019, 58, 839–849. [Google Scholar] [CrossRef]
- Farrar, J.E.; Schuback, H.L.; Ries, R.E.; Wai, D.; Hampton, O.A.; Trevino, L.R.; Alonzo, T.A.; Guidry Auvil, J.M.; Davidsen, T.M.; Gesuwan, P.; et al. Genomic Profiling of Pediatric Acute Myeloid Leukemia Reveals a Changing Mutational Landscape from Disease Diagnosis to Relapse. Cancer Res. 2016, 76, 2197–2205. [Google Scholar] [CrossRef] [PubMed]
- Shiba, N.; Yoshida, K.; Shiraishi, Y.; Okuno, Y.; Yamato, G.; Hara, Y.; Nagata, Y.; Chiba, K.; Tanaka, H.; Terui, K.; et al. Whole-Exome Sequencing Reveals the Spectrum of Gene Mutations and the Clonal Evolution Patterns in Paediatric Acute Myeloid Leukaemia. Br. J. Haematol. 2016, 175, 476–489. [Google Scholar] [CrossRef]
- Masetti, R.; Castelli, I.; Astolfi, A.; Bertuccio, S.N.; Indio, V.; Togni, M.; Belotti, T.; Serravalle, S.; Tarantino, G.; Zecca, M.; et al. Genomic Complexity and Dynamics of Clonal Evolution in Childhood Acute Myeloid Leukemia Studied with Whole-Exome Sequencing. Oncotarget 2016, 7, 56746–56757. [Google Scholar] [CrossRef]
- Salman, H.; Shuai, X.; Nguyen-Lefebvre, A.T.; Giri, B.; Ren, M.; Rauchman, M.; Robbins, L.; Hou, W.; Korkaya, H.; Ma, Y. SALL1 Expression in Acute Myeloid Leukemia. Oncotarget 2018, 9, 7442–7452. [Google Scholar] [CrossRef]
- Schuurhuis, G.J.; Heuser, M.; Freeman, S.; Béné, M.-C.; Buccisano, F.; Cloos, J.; Grimwade, D.; Haferlach, T.; Hills, R.K.; Hourigan, C.S.; et al. Minimal/Measurable Residual Disease in AML: A Consensus Document from the European LeukemiaNet MRD Working Party. Blood 2018, 131, 1275–1291. [Google Scholar] [CrossRef] [PubMed]
- Segerink, W.H.; de Haas, V.; Kaspers, G.J.L. Measurable Residual Disease in Pediatric Acute Myeloid Leukemia: A Systematic Review. Expert Rev. Anticancer. Ther. 2021, 21, 451–459. [Google Scholar] [CrossRef] [PubMed]
- Klein, K.; de Haas, V.; Kaspers, G.J.L. Clinical Challenges in de Novo Pediatric Acute Myeloid Leukemia. Expert Rev. Anticancer. Ther. 2018, 18, 277–293. [Google Scholar] [CrossRef]
- Short, N.J.; Zhou, S.; Fu, C.; Berry, D.A.; Walter, R.B.; Freeman, S.D.; Hourigan, C.S.; Huang, X.; Nogueras Gonzalez, G.; Hwang, H.; et al. Association of Measurable Residual Disease with Survival Outcomes in Patients with Acute Myeloid Leukemia: A Systematic Review and Meta-Analysis. JAMA Oncol. 2020, 6, 1890–1899. [Google Scholar] [CrossRef]
- Paietta, E. Consensus on MRD in AML? Blood 2018, 131, 1265–1266. [Google Scholar] [CrossRef]
- Shaffer, B.C.; Kebriaei, P.; de Lima, M.; Jimenez Jimenez, A.M. Measurable Residual Disease Testing and Allogeneic Hematopoietic Cell Transplantation for AML: Adapting Pre-MEASURE to Clinical Practice. Bone Marrow Transpl. 2025, 60, 128–134. [Google Scholar] [CrossRef]
- Tettero, J.M.; Freeman, S.; Buecklein, V.; Venditti, A.; Maurillo, L.; Kern, W.; Walter, R.B.; Wood, B.L.; Roumier, C.; Philippé, J.; et al. Technical Aspects of Flow Cytometry-Based Measurable Residual Disease Quantification in Acute Myeloid Leukemia: Experience of the European LeukemiaNet MRD Working Party. Hemasphere 2022, 6, e676, Erratum in Hemasphere 2022, 6, e703. [Google Scholar] [CrossRef]
- Heuser, M.; Freeman, S.D.; Ossenkoppele, G.J.; Buccisano, F.; Hourigan, C.S.; Ngai, L.L.; Tettero, J.M.; Bachas, C.; Baer, C.; Béné, M.-C.; et al. 2021 Update on MRD in Acute Myeloid Leukemia: A Consensus Document from the European LeukemiaNet MRD Working Party. Blood 2021, 138, 2753–2767. [Google Scholar] [CrossRef]
- Feller, N.; van der Pol, M.A.; van Stijn, A.; Weijers, G.W.D.; Westra, A.H.; Evertse, B.W.; Ossenkoppele, G.J.; Schuurhuis, G.J. MRD Parameters Using Immunophenotypic Detection Methods Are Highly Reliable in Predicting Survival in Acute Myeloid Leukaemia. Leukemia 2004, 18, 1380–1390. [Google Scholar] [CrossRef] [PubMed]
- Brooimans, R.A.; van der Velden, V.H.J.; Boeckx, N.; Slomp, J.; Preijers, F.; Te Marvelde, J.G.; Van, N.M.; Heijs, A.; Huys, E.; van der Holt, B.; et al. Immunophenotypic Measurable Residual Disease (MRD) in Acute Myeloid Leukemia: Is Multicentric MRD Assessment Feasible? Leuk. Res. 2019, 76, 39–47. [Google Scholar] [CrossRef] [PubMed]
- Wood, B.L. Acute Myeloid Leukemia Minimal Residual Disease Detection: The Difference from Normal Approach. Curr. Protoc. Cytom. 2020, 93, e73. [Google Scholar] [CrossRef]
- Hourigan, C.S.; Gale, R.P.; Gormley, N.J.; Ossenkoppele, G.J.; Walter, R.B. Measurable Residual Disease Testing in Acute Myeloid Leukaemia. Leukemia 2017, 31, 1482–1490. [Google Scholar] [CrossRef]
- Ngai, L.L.; Kelder, A.; Janssen, J.J.W.M.; Ossenkoppele, G.J.; Cloos, J. MRD Tailored Therapy in AML: What We Have Learned So Far. Front. Oncol. 2020, 10, 603636. [Google Scholar] [CrossRef]
- Allan, J.M. Genetic Susceptibility to Breast Cancer in Lymphoma Survivors. Blood 2019, 133, 1004–1006. [Google Scholar] [CrossRef]
- Nguyen, S.; Leblanc, T.; Fenaux, P.; Witz, F.; Blaise, D.; Pigneux, A.; Thomas, X.; Rigal-Huguet, F.; Lioure, B.; Auvrignon, A.; et al. A White Blood Cell Index as the Main Prognostic Factor in t(8;21) Acute Myeloid Leukemia (AML): A Survey of 161 Cases from the French AML Intergroup. Blood 2002, 99, 3517–3523. [Google Scholar] [CrossRef]
- Wilde, L.; Cooper, J.; Wang, Z.-X.; Liu, J. Clinical, Cytogenetic, and Molecular Findings in Two Cases of Variant t(8;21) Acute Myeloid Leukemia (AML). Front. Oncol. 2019, 9, 1016. [Google Scholar] [CrossRef]
- Al-Harbi, S.; Aljurf, M.; Mohty, M.; Almohareb, F.; Ahmed, S.O.A. An Update on the Molecular Pathogenesis and Potential Therapeutic Targeting of AML with t(8;21)(Q22;Q22.1);RUNX1-RUNX1T1. Blood Adv. 2020, 4, 229–238. [Google Scholar] [CrossRef]
- Mikhailova, E.V.; Kashpor, S.A.; Zerkalenkova, E.A.; Semchenkova, A.A.; Dubrovina, M.E.; Plyasunova, S.A.; Olshanskaya, Y.V.; Kalinina, I.I.; Maschan, M.A.; Maschan, A.A.; et al. Immunophenotypic characterization of pediatric acute myeloid leukemia with inv(16)(p13.1q22)/t(16;16)(p13.1;q22)/CBFb-MYH11. Pediatr. Hematol. Oncol. Immunopathol. 2021, 20, 46–53. [Google Scholar] [CrossRef]
- Cordonnier, G.; Mandoli, A.; Cagnard, N.; Hypolite, G.; Lhermitte, L.; Verhoeyen, E.; Asnafi, V.; Dillon, N.; Macintyre, E.; Martens, J.H.A.; et al. CBFβ-SMMHC Affects Genome-Wide Polycomb Repressive Complex 1 Activity in Acute Myeloid Leukemia. Cell Rep. 2020, 30, 299–307.e3. [Google Scholar] [CrossRef]
- Papadakis, S.; Liapis, I.; Papadhimitriou, S.I.; Spanoudakis, E.; Kotsianidis, I.; Liapis, K. Approach to Acute Myeloid Leukemia with Increased Eosinophils and Basophils. J. Clin. Med. 2024, 13, 876. [Google Scholar] [CrossRef]
- Ustun, C.; Marcucci, G. Emerging Diagnostic and Therapeutic Approaches in Core Binding Factor Acute Myeloid Leukaemia. Curr. Opin. Hematol. 2015, 22, 85–91. [Google Scholar] [CrossRef]
- Klein, K.; Kaspers, G.; Harrison, C.J.; Beverloo, H.B.; Reedijk, A.; Bongers, M.; Cloos, J.; Pession, A.; Reinhardt, D.; Zimmerman, M.; et al. Clinical Impact of Additional Cytogenetic Aberrations, cKIT and RAS Mutations, and Treatment Elements in Pediatric t(8;21)-AML: Results from an International Retrospective Study by the International Berlin-Frankfurt-Münster Study Group. J. Clin. Oncol. 2015, 33, 4247–4258. [Google Scholar] [CrossRef]
- Solh, M.; Yohe, S.; Weisdorf, D.; Ustun, C. Core-Binding Factor Acute Myeloid Leukemia: Heterogeneity, Monitoring, and Therapy. Am. J. Hematol. 2014, 89, 1121–1131. [Google Scholar] [CrossRef]
- Liao, X.; Fang, J.; Zhou, D.; Qiu, K. CEBPA Are Independent Good Prognostic Factors in Pediatric Acute Myeloid Leukemia. Hematol. Oncol. 2022, 40, 258–268. [Google Scholar] [CrossRef]
- Tarlock, K.; Lamble, A.J.; Wang, Y.-C.; Gerbing, R.B.; Ries, R.E.; Loken, M.R.; Brodersen, L.E.; Pardo, L.; Leonti, A.; Smith, J.L.; et al. CEBPA-bZip Mutations Are Associated with Favorable Prognosis in de Novo AML: A Report from the Children’s Oncology Group. Blood 2021, 138, 1137–1147, Erratum in Blood 2022, 139, 1601. [Google Scholar] [CrossRef]
- Elgarten, C.W.; Aplenc, R. Pediatric Acute Myeloid Leukemia: Updates on Biology, Risk Stratification, and Therapy. Curr. Opin. Pediatr. 2020, 32, 57–66. [Google Scholar] [CrossRef]
- Ranieri, R.; Pianigiani, G.; Sciabolacci, S.; Perriello, V.M.; Marra, A.; Cardinali, V.; Pierangeli, S.; Milano, F.; Gionfriddo, I.; Brunetti, L.; et al. Current Status and Future Perspectives in Targeted Therapy of NPM1-Mutated AML. Leukemia 2022, 36, 2351–2367. [Google Scholar] [CrossRef]
- Falini, B.; Sorcini, D.; Perriello, V.M.; Sportoletti, P. Functions of the Native NPM1 Protein and Its Leukemic Mutant. Leukemia 2025, 39, 276–290. [Google Scholar] [CrossRef]
- Kiyoi, H.; Kawashima, N.; Ishikawa, Y. FLT3 Mutations in Acute Myeloid Leukemia: Therapeutic Paradigm beyond Inhibitor Development. Cancer Sci. 2020, 111, 312–322. [Google Scholar] [CrossRef]
- Cantilena, S.; Gasparoli, L.; Pal, D.; Heidenreich, O.; Klusmann, J.-H.; Martens, J.H.A.; Faille, A.; Warren, A.J.; Karsa, M.; Pandher, R.; et al. Direct Targeted Therapy for MLL-Fusion-Driven High-Risk Acute Leukaemias. Clin. Transl. Med. 2022, 12, e933. [Google Scholar] [CrossRef]
- Schurer, A.; Glushakow-Smith, S.G.; Gritsman, K. Targeting Chromatin Modifying Complexes in Acute Myeloid Leukemia. Stem Cells Transl. Med. 2025, 14, szae089. [Google Scholar] [CrossRef]
- Meyer, C.; Larghero, P.; Almeida Lopes, B.; Burmeister, T.; Gröger, D.; Sutton, R.; Venn, N.C.; Cazzaniga, G.; Corral Abascal, L.; Tsaur, G.; et al. The KMT2A Recombinome of Acute Leukemias in 2023. Leukemia 2023, 37, 988–1005. [Google Scholar] [CrossRef]
- Hu, H.; Muntean, A.G. The YEATS Domain Epigenetic Reader Proteins ENL and AF9 and Their Therapeutic Value in Leukemia. Exp. Hematol. 2023, 124, 15–21. [Google Scholar] [CrossRef]
- Schneider, P.; Crump, N.T.; Arentsen-Peters, S.T.C.J.M.; Smith, A.L.; Hagelaar, R.; Adriaanse, F.R.S.; Bos, R.S.; de Jong, A.; Nierkens, S.; Koopmans, B.; et al. Modelling Acquired Resistance to DOT1L Inhibition Exhibits the Adaptive Potential of KMT2A-Rearranged Acute Lymphoblastic Leukemia. Exp. Hematol. Oncol. 2023, 12, 81. [Google Scholar] [CrossRef]
- Yi, Y.; Ge, S. Targeting the Histone H3 Lysine 79 Methyltransferase DOT1L in MLL-Rearranged Leukemias. J. Hematol. Oncol. 2022, 15, 35. [Google Scholar] [CrossRef]
- Quessada, J.; Cuccuini, W.; Saultier, P.; Loosveld, M.; Harrison, C.J.; Lafage-Pochitaloff, M. Cytogenetics of Pediatric Acute Myeloid Leukemia: A Review of the Current Knowledge. Genes 2021, 12, 924. [Google Scholar] [CrossRef]
- Waack, K.; Schneider, M.; Walter, C.; Creutzig, U.; Klusmann, J.-H.; Rasche, M.; Boztug, H.; Jansen, K.; Escherich, G.; Frühwald, M.; et al. Improved Outcome in Pediatric AML—The AML-BFM 2012 Study. Blood 2020, 136, 12–14. [Google Scholar] [CrossRef]
- Noort, S.; Zimmermann, M.; Reinhardt, D.; Cuccuini, W.; Pigazzi, M.; Smith, J.; Ries, R.E.; Alonzo, T.A.; Hirsch, B.; Tomizawa, D.; et al. Prognostic Impact of t(16;21)(P11;Q22) and t(16;21)(Q24;Q22) in Pediatric AML: A Retrospective Study by the I-BFM Study Group. Blood 2018, 132, 1584–1592. [Google Scholar] [CrossRef]
- Balgobind, B.V.; Raimondi, S.C.; Harbott, J.; Zimmermann, M.; Alonzo, T.A.; Auvrignon, A.; Beverloo, H.B.; Chang, M.; Creutzig, U.; Dworzak, M.N.; et al. Novel Prognostic Subgroups in Childhood 11q23/MLL-Rearranged Acute Myeloid Leukemia: Results of an International Retrospective Study. Blood 2009, 114, 2489–2496. [Google Scholar] [CrossRef]
- Pearson, A.D.J.; Zwaan, C.M.; Kolb, E.A.; Karres, D.; Guillot, J.; Kim, S.Y.; Marshall, L.; Tasian, S.K.; Smith, M.; Cooper, T.; et al. Paediatric Strategy Forum for Medicinal Product Development for Acute Myeloid Leukaemia in Children and Adolescents: ACCELERATE in Collaboration with the European Medicines Agency with Participation of the Food and Drug Administration. Eur. J. Cancer 2020, 136, 116–129. [Google Scholar] [CrossRef]
- Kim, H. Treatments for Children and Adolescents with AML. Blood Res. 2020, 55, S5–S13. [Google Scholar] [CrossRef]
- Obszański, P.; Kozłowska, A.; Wańcowiat, J.; Twardowska, J.; Lejman, M.; Zawitkowska, J. Molecular-Targeted Therapy of Pediatric Acute Myeloid Leukemia. Molecules 2022, 27, 3911. [Google Scholar] [CrossRef]
- Iyer, P. Pediatric AML: State of the Art and Future Directions. Pediatr. Hematol. Oncol. 2025, 42, 126–145. [Google Scholar] [CrossRef]
- Leger, K.J.; Absalon, M.J.; Demissei, B.G.; Smith, A.M.; Gerbing, R.B.; Alonzo, T.A.; Narayan, H.K.; Hirsch, B.A.; Pollard, J.A.; Razzouk, B.I.; et al. Cardiotoxicity of CPX-351 in Children and Adolescents with Relapsed AML: A Children’s Oncology Group Report. Front. Cardiovasc. Med. 2024, 11, 1347547. [Google Scholar] [CrossRef]
- Cooper, T.M.; Absalon, M.J.; Alonzo, T.A.; Gerbing, R.B.; Leger, K.J.; Hirsch, B.A.; Pollard, J.; Razzouk, B.I.; Aplenc, R.; Kolb, E.A. Phase I/II Study of CPX-351 Followed by Fludarabine, Cytarabine, and Granulocyte-Colony Stimulating Factor for Children with Relapsed Acute Myeloid Leukemia: A Report from the Children’s Oncology Group. J. Clin. Oncol. 2020, 38, 2170–2177. [Google Scholar] [CrossRef]
- Pollard, J.A.; Guest, E.; Alonzo, T.A.; Gerbing, R.B.; Loken, M.R.; Brodersen, L.E.; Kolb, E.A.; Aplenc, R.; Meshinchi, S.; Raimondi, S.C.; et al. Gemtuzumab Ozogamicin Improves Event-Free Survival and Reduces Relapse in Pediatric KMT2A-Rearranged AML: Results from the Phase III Children’s Oncology Group Trial AAML0531. J. Clin. Oncol. 2021, 39, 3149–3160. [Google Scholar] [CrossRef]
- Blain, S.; Payette, N.; Bittencourt, H.; Johnston, D.L. Gemtuzumab Ozogamicin Monotherapy Is a Well-Tolerated Palliative Chemotherapy Option in Pediatric Multiply Relapsed Acute Myeloid Leukemia: A Multicenter Case Series and Review of the Literature. J. Pediatr. Hematol. Oncol. 2023, 45, 436–444. [Google Scholar] [CrossRef]
- Stokke, J.L.; Bhojwani, D. Antibody-Drug Conjugates for the Treatment of Acute Pediatric Leukemia. J. Clin. Med. 2021, 10, 3556. [Google Scholar] [CrossRef]
- Egan, G.; Chopra, Y.; Mourad, S.; Chiang, K.-Y.; Hitzler, J. Treatment of Acute Myeloid Leukemia in Children: A Practical Perspective. Pediatr. Blood Cancer 2021, 68, e28979. [Google Scholar] [CrossRef]
- Pollard, J.A.; Alonzo, T.A.; Gerbing, R.; Brown, P.; Fox, E.; Choi, J.; Fisher, B.; Hirsch, B.; Kahwash, S.; Getz, K.; et al. Sorafenib in Combination with Standard Chemotherapy for Children with High Allelic Ratio FLT3/ITD+ Acute Myeloid Leukemia: A Report from the Children’s Oncology Group Protocol AAML1031. J. Clin. Oncol. 2022, 40, 2023–2035. [Google Scholar] [CrossRef] [PubMed]
- Conneely, S.E.; Stevens, A.M. Acute Myeloid Leukemia in Children: Emerging Paradigms in Genetics and New Approaches to Therapy. Curr. Oncol. Rep. 2021, 23, 16. [Google Scholar] [CrossRef] [PubMed]
- Aplenc, R.; Meshinchi, S.; Sung, L.; Alonzo, T.; Choi, J.; Fisher, B.; Gerbing, R.; Hirsch, B.; Horton, T.; Kahwash, S.; et al. Bortezomib with Standard Chemotherapy for Children with Acute Myeloid Leukemia Does Not Improve Treatment Outcomes: A Report from the Children’s Oncology Group. Haematologica 2020, 105, 1879–1886. [Google Scholar] [CrossRef] [PubMed]
- Ramiz, S.; Elhaj, O.; Siddiqui, K.; Khan, S.; AlSaedi, H.; AlAnazi, A.; Al-Ahmari, A.; Al-Jefri, A.; Sahvan, O.; Ayas, M.; et al. Clofarabine in Pediatric Acute Relapsed or Refractory Leukemia: Where Do We Stand on the Bridge to Hematopoietic Stem Cell Transplantation? J. Hematol. 2023, 12, 16–26. [Google Scholar] [CrossRef]
- Chen, J.; Glasser, C.L. New and Emerging Targeted Therapies for Pediatric Acute Myeloid Leukemia (AML). Children 2020, 7, 12. [Google Scholar] [CrossRef]
- Marszołek, A.; Leśniak, M.; Sekunda, A.; Siwek, A.; Skiba, Z.; Lejman, M.; Zawitkowska, J. Haploidentical HSCT in the Treatment of Pediatric Hematological Disorders. Int. J. Mol. Sci. 2024, 25, 6380. [Google Scholar] [CrossRef]
- Zarnegar-Lumley, S.; Caldwell, K.J.; Rubnitz, J.E. Relapsed Acute Myeloid Leukemia in Children and Adolescents: Current Treatment Options and Future Strategies. Leukemia 2022, 36, 1951–1960. [Google Scholar] [CrossRef]
- Tseng, S.; Lee, M.-E.; Lin, P.-C. A Review of Childhood Acute Myeloid Leukemia: Diagnosis and Novel Treatment. Pharmaceuticals 2023, 16, 1614. [Google Scholar] [CrossRef]
- Rasche, M.; Zimmermann, M.; Steidel, E.; Alonzo, T.; Aplenc, R.; Bourquin, J.-P.; Boztug, H.; Cooper, T.; Gamis, A.S.; Gerbing, R.B.; et al. Survival Following Relapse in Children with Acute Myeloid Leukemia: A Report from AML-BFM and COG. Cancers 2021, 13, 2336. [Google Scholar] [CrossRef]
- Tarlock, K.; Sulis, M.L.; Chewning, J.H.; Pollard, J.A.; Cooper, T.; Gamis, A.; Shenoy, S.; Kutny, M.; Horan, J.; Meshinchi, S.; et al. Hematopoietic Cell Transplantation in the Treatment of Pediatric Acute Myelogenous Leukemia and Myelodysplastic Syndromes: Guidelines from the American Society of Transplantation and Cellular Therapy. Transplant. Cell. Ther. 2022, 28, 530–545. [Google Scholar] [CrossRef] [PubMed]
- Sauer, M.G.; Lang, P.J.; Albert, M.H.; Bader, P.; Creutzig, U.; Eyrich, M.; Greil, J.; Gruhn, B.; Holter, W.; Klingebiel, T.; et al. Hematopoietic Stem Cell Transplantation for Children with Acute Myeloid Leukemia-Results of the AML SCT-BFM 2007 Trial. Leukemia 2020, 34, 613–624, Erratum in Leukemia 2020, 34, 1486. [Google Scholar] [CrossRef]
- Versluijs, A.B.; de Koning, C.C.H.; Lankester, A.C.; Nierkens, S.; Kollen, W.J.; Bresters, D.; Lindemans, C.A.; Boelens, J.J.; Bierings, M. Clofarabine-Fludarabine-Busulfan in HCT for Pediatric Leukemia: An Effective, Low Toxicity, TBI-Free Conditioning Regimen. Blood Adv. 2022, 6, 1719–1730. [Google Scholar] [CrossRef]
- Versluys, A.B.; Boelens, J.J.; Pronk, C.; Lankester, A.; Bordon, V.; Buechner, J.; Ifversen, M.; Jackmann, N.; Sundin, M.; Vettenranta, K.; et al. Hematopoietic Cell Transplant in Pediatric Acute Myeloid Leukemia after Similar Upfront Therapy; a Comparison of Conditioning Regimens. Bone Marrow Transplant. 2021, 56, 1426–1432, Erratum in Bone Marrow Transplant. 2021, 56, 1485. [Google Scholar] [CrossRef] [PubMed]
- Scott, B.L.; Pasquini, M.C.; Fei, M.; Fraser, R.; Wu, J.; Devine, S.M.; Porter, D.L.; Maziarz, R.T.; Warlick, E.; Fernandez, H.F.; et al. Myeloablative versus Reduced-Intensity Conditioning for Hematopoietic Cell Transplantation in Acute Myelogenous Leukemia and Myelodysplastic Syndromes-Long-Term Follow-Up of the BMT CTN 0901 Clinical Trial. Transplant. Cell. Ther. 2021, 27, 483.e1–483.e6. [Google Scholar] [CrossRef]
- Guillaume, T.; Thépot, S.; Peterlin, P.; Ceballos, P.; Bourgeois, A.L.; Garnier, A.; Orvain, C.; Giltat, A.; François, S.; Bris, Y.L.; et al. Prophylactic or Preemptive Low-Dose Azacitidine and Donor Lymphocyte Infusion to Prevent Disease Relapse Following Allogeneic Transplantation in Patients with High-Risk Acute Myelogenous Leukemia or Myelodysplastic Syndrome. Transplant. Cell. Ther. 2021, 27, 839.e1–839.e6. [Google Scholar] [CrossRef] [PubMed]
- Klimentova, M.; Shelikhova, L.; Ilushina, M.; Kozlovskaya, S.; Blagov, S.; Popov, A.; Kashpor, S.; Fadeeva, M.; Olshanskaya, J.; Glushkova, S.; et al. Targeted Therapy with Venetoclax and Daratumumab as Part of HSCT Preparative Regimen in Children with Chemorefractory Acute Myeloid Leukemia. Transplant. Cell. Ther. 2023, 29, 127.e1–127.e9. [Google Scholar] [CrossRef]
- Daver, N.; Schlenk, R.F.; Russell, N.H.; Levis, M.J. Targeting FLT3 Mutations in AML: Review of Current Knowledge and Evidence. Leukemia 2019, 33, 299–312. [Google Scholar] [CrossRef]
- Negotei, C.; Colita, A.; Mitu, I.; Lupu, A.R.; Lapadat, M.-E.; Popovici, C.E.; Crainicu, M.; Stanca, O.; Berbec, N.M. A Review of FLT3 Kinase Inhibitors in AML. J. Clin. Med. 2023, 12, 6429. [Google Scholar] [CrossRef] [PubMed]
- Kapoor, I.; Bodo, J.; Hill, B.T.; Hsi, E.D.; Almasan, A. Targeting BCL-2 in B-Cell Malignancies and Overcoming Therapeutic Resistance. Cell Death Dis. 2020, 11, 941. [Google Scholar] [CrossRef]
- Roberts, A.W.; Wei, A.H.; Huang, D.C.S. BCL2 and MCL1 Inhibitors for Hematologic Malignancies. Blood 2021, 138, 1120–1136. [Google Scholar] [CrossRef] [PubMed]
- Thakur, R.K.; Wang, E.S. Top Advances of the Year: Acute Myeloid Leukemia. Cancer 2025, 131, e35834. [Google Scholar] [CrossRef]
- Jones, L.M.; Tarlock, K.; Cooper, T. Targeted Therapy in Pediatric AML: An Evolving Landscape. Paediatr. Drugs 2021, 23, 485–497. [Google Scholar] [CrossRef] [PubMed]
- Kwon, M.C.; Thuring, J.W.; Querolle, O.; Dai, X.; Verhulst, T.; Pande, V.; Marien, A.; Goffin, D.; Wenge, D.V.; Yue, H.; et al. Preclinical Efficacy of the Potent, Selective Menin-KMT2A Inhibitor JNJ-75276617 (Bleximenib) in KMT2A- and NPM1-Altered Leukemias. Blood 2024, 144, 1206–1220. [Google Scholar] [CrossRef]
- Wang, Q.; Hao, S. A-1210477, a Selective MCL-1 Inhibitor, Overcomes ABT-737 Resistance in AML. Oncol. Lett. 2019, 18, 5481–5489. [Google Scholar] [CrossRef]
- Neuendorff, N.R.; Gagelmann, N.; Singhal, S.; Meckstroth, S.; Thibaud, V.; Zhao, Y.; Mir, N.; Shih, Y.-Y.; Amaro, D.M.C.; Roy, M.; et al. Hypomethylating Agent-Based Therapies in Older Adults with Acute Myeloid Leukemia—A Joint Review by the Young International Society of Geriatric Oncology and European Society for Blood and Marrow Transplantation Trainee Committee. J. Geriatr. Oncol. 2023, 14, 101406. [Google Scholar] [CrossRef]
- San José-Enériz, E.; Gimenez-Camino, N.; Agirre, X.; Prosper, F. HDAC Inhibitors in Acute Myeloid Leukemia. Cancers 2019, 11, 1794. [Google Scholar] [CrossRef]
- Yang, D.; Zhang, X.; Zhang, X.; Xu, Y. The Progress and Current Status of Immunotherapy in Acute Myeloid Leukemia. Ann. Hematol. 2017, 96, 1965–1982. [Google Scholar] [CrossRef]
- Perzolli, A.; Koedijk, J.B.; Zwaan, C.M.; Heidenreich, O. Targeting the Innate Immune System in Pediatric and Adult AML. Leukemia 2024, 38, 1191–1201. [Google Scholar] [CrossRef]
- Verma, A.; Chi, Y.-Y.; Malvar, J.; Lamble, A.; Chaudhury, S.; Agarwal, A.; Li, H.-T.; Liang, G.; Leong, R.; Brown, P.A.; et al. Nivolumab Plus 5-Azacitidine in Pediatric Relapsed/Refractory Acute Myeloid Leukemia (AML): Phase I/II Trial Results from the Therapeutic Advances in Childhood Leukemia and Lymphoma (TACL) Consortium. Cancers 2024, 16, 496. [Google Scholar] [CrossRef]
- Davis, K.L.; Agarwal, A.M.; Verma, A.R. Checkpoint Inhibition in Pediatric Hematologic Malignancies. Pediatr. Hematol. Oncol. 2017, 34, 379–394. [Google Scholar] [CrossRef] [PubMed]
- Epperly, R.; Gottschalk, S.; Velasquez, M.P. Harnessing T Cells to Target Pediatric Acute Myeloid Leukemia: CARs, BiTEs, and Beyond. Children 2020, 7, 14. [Google Scholar] [CrossRef] [PubMed]
- Menssen, A.J.; Hudson, C.A.; Alonzo, T.; Gerbing, R.; Pardo, L.; Leonti, A.; Cook, J.A.; Hsu, F.-C.; Lott, L.L.; Dai, F.; et al. CD74 Is Expressed in a Subset of Pediatric Acute Myeloid Leukemia Patients and Is a Promising Target for Therapy: A Report from the Children’s Oncology Group. Haematologica 2024, 109, 3182–3193. [Google Scholar] [CrossRef] [PubMed]
- Krizsán, S.; Péterffy, B.; Egyed, B.; Nagy, T.; Sebestyén, E.; Hegyi, L.L.; Jakab, Z.; Erdélyi, D.J.; Müller, J.; Péter, G.; et al. Next-Generation Sequencing-Based Genomic Profiling of Children with Acute Myeloid Leukemia. J. Mol. Diagn. 2023, 25, 555–568. [Google Scholar] [CrossRef]
- Hammer, A.S.B.; Juul-Dam, K.L.; Sandahl, J.D.; Abrahamsson, J.; Czogala, M.; Delabesse, E.; Haltrich, I.; Jahnukainen, K.; Kolb, E.A.; Kovács, G.; et al. Hypodiploidy Has Unfavorable Impact on Survival in Pediatric Acute Myeloid Leukemia: An I-BFM Study Group Collaboration. Blood Adv. 2023, 7, 1045–1055. [Google Scholar] [CrossRef]
- Ruan, M.; Liu, L.; Qi, B.; Chen, X.; Chang, L.; Zhang, A.; Liu, F.; Wang, S.; Liu, X.; Chen, X.; et al. Targeted Next-Generation Sequencing of Circulating Tumor DNA, Bone Marrow, and Peripheral Blood Mononuclear Cells in Pediatric AML. Front. Oncol. 2021, 11, 666470. [Google Scholar] [CrossRef]
- Said, F.; Tantawy, M.; Sayed, A.; Ahmed, S. Clinical Significance of MicroRNA-29a and MicroRNA-100 Gene Expression in Pediatric Acute Myeloid Leukemia. J. Pediatr. Hematol. Oncol. 2022, 44, e391–e395, Erratum in J. Pediatr. Hematol. Oncol. 2022, 44, 272. [Google Scholar] [CrossRef]
- Cao, J.; Xie, M.; Sun, K.; Zhao, Y.; Zheng, J.; Wang, Y.; Zheng, Y.; Liu, S.; Yu, U. Development of a Prognostic Model Incorporating a Cuproptosis-Related Signature and CNN3 as a Predictor in Childhood Acute Myelocytic Leukemia. Front. Oncol. 2024, 14, 1494777. [Google Scholar] [CrossRef]
- Ellson, I.; Martorell-Marugán, J.; Carmona-Sáez, P.; Ramos-Mejia, V. MiRNA Expression as Outcome Predictor in Pediatric AML: Systematic Evaluation of a New Model. NPJ Genom. Med. 2024, 9, 40. [Google Scholar] [CrossRef]
- Moshref Razavi, H.; Minor, A. A Case of AML with Complex Karyotype and Chromosomal Rearrangement of KMT2A. Clin. Case Rep. 2024, 12, e9139. [Google Scholar] [CrossRef]
- Pais, A.; Pande, S.; Pradhan, G.; Patil, S. A Complex Karyotype with t(11;12)(Q23;P13) Translocation with Coexistent Clones of Deletion 5q and Cryptic Deletion 7q in Acute Myeloid Leukemia. Indian J. Cancer 2020, 57, 330. [Google Scholar] [CrossRef] [PubMed]
- Capela de Matos, R.R.; Ney Garcia, D.R.; Othman, M.A.K.; Moura Ferreira, G.; Melo, J.B.; Carreira, I.M.; Meyer, C.; Marschalek, R.; Costa, E.S.; Land, M.G.P.; et al. A New Complex Karyotype Involving a KMT2A-r Variant Three-Way Translocation in a Rare Clinical Presentation of a Pediatric Patient with Acute Myeloid Leukemia. Cytogenet. Genome Res. 2019, 157, 213–219. [Google Scholar] [CrossRef] [PubMed]
- Grimwade, D.; Walker, H.; Harrison, G.; Oliver, F.; Chatters, S.; Harrison, C.J.; Wheatley, K.; Burnett, A.K.; Goldstone, A.H.; Medical Research Council Adult Leukemia Working Party. The Predictive Value of Hierarchical Cytogenetic Classification in Older Adults with Acute Myeloid Leukemia (AML): Analysis of 1065 Patients Entered into the United Kingdom Medical Research Council AML11 Trial. Blood 2001, 98, 1312–1320. [Google Scholar] [CrossRef] [PubMed]
- Slovak, M.L.; Kopecky, K.J.; Cassileth, P.A.; Harrington, D.H.; Theil, K.S.; Mohamed, A.; Paietta, E.; Willman, C.L.; Head, D.R.; Rowe, J.M.; et al. Karyotypic Analysis Predicts Outcome of Preremission and Postremission Therapy in Adult Acute Myeloid Leukemia: A Southwest Oncology Group/Eastern Cooperative Oncology Group Study. Blood 2000, 96, 4075–4083. [Google Scholar] [CrossRef]
- Fröhling, S.; Schlenk, R.F.; Kayser, S.; Morhardt, M.; Benner, A.; Döhner, K.; Döhner, H.; German-Austrian AML Study Group. Cytogenetics and Age Are Major Determinants of Outcome in Intensively Treated Acute Myeloid Leukemia Patients Older than 60 Years: Results from AMLSG Trial AML HD98-B. Blood 2006, 108, 3280–3288. [Google Scholar] [CrossRef]
- Chen, X.; Wang, X.; Dou, H.; Yang, Z.; Bi, J.; Huang, Y.; Lu, L.; Yu, J.; Bao, L. Cytogenetic and Mutational Analysis and Outcome Assessment of a Cohort of 284 Children with de Novo Acute Myeloid Leukemia Reveal Complex Karyotype as an Adverse Risk Factor for Inferior Survival. Mol. Cytogenet. 2021, 14, 27. [Google Scholar] [CrossRef]
- Lee, N.H.; Choi, Y.B.; Yi, E.-S.; Lee, S.H.; Kim, H.-J.; Lee, J.W.; Sung, K.W.; Koo, H.H.; Yoo, K.H. Monosomal Karyotype Is Not a Predictor of Dismal Outcome in Childhood de Novo Acute Myeloid Leukemia. Leuk. Res. 2016, 50, 57–62. [Google Scholar] [CrossRef] [PubMed]
Disclaimer/Publisher’s Note: The statements, opinions and data contained in all publications are solely those of the individual author(s) and contributor(s) and not of MDPI and/or the editor(s). MDPI and/or the editor(s) disclaim responsibility for any injury to people or property resulting from any ideas, methods, instructions or products referred to in the content. |
© 2025 by the authors. Licensee MDPI, Basel, Switzerland. This article is an open access article distributed under the terms and conditions of the Creative Commons Attribution (CC BY) license (https://creativecommons.org/licenses/by/4.0/).